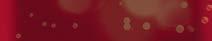

![]()








































































































































The White Lotus: Aimee Lou’s tanden verdienen een Emmy 64


Scheidingsfeestjes! En opeens was er taart met z’n hoofd erop























82 Katten: Van energiebom naar bankhanger in 3, 2, 1...




48 Argentinië: Op reis door het land van Máxima



Op de rode loper van Hollywood, waar elke kies gepolijst en elk spleetje gesponsord is, komt ineens Aimee Lou Wood aanzetten. Britse actrice, The White Lotus seizoen 3, personage Chelsea. En ze lacht. Niet zo’n glimlach die weerkaatst op twaalf porseleinen facings, maar een echte. Met tanden. Mensentanden.
Een charmante overbeet. Een tikje schots en scheef. En in één klap is ze de knapste vrouw op de set. Niet ondanks die tanden, maar juist daarom. En ze is niet de enige. Ook Charlotte Le Bon – Chelsea’s vriendin in The White Lotus – grijnst met karakter. Haar tanden brengen een krasje aan in haar verder perfecte uiterlijk. En dat is precies wat haar menselijk maakt.
DenD schuwt de gevoelige snaren niet. In dit nummer duiken we in het fenomeen scheidingsfeest: niet alleen een wraakoefening (de traditie waarbij je je ex ceremonieel in plakjes zaagt met een plastic taartmes leeft nog altijd voort), maar een nieuw soort afscheidsritueel mét co-ouderschapsplanning en prosecco (véél prosecco).
Verder: de 25 Nederlandse talenten van morgen. Van briljante bètakoppen tot creatieve breinen en stille krachtpatsers.
Veel leesplezier — en lach. Desnoods met je eigen tanden. Zoals Aimee Lou Wood.
Anette de Vries



Elke maand meer dan 3,5 miljoen kijkers!










Wil jij ook op deze pagina verschijnen?
Stuur een e-mail naar: commercie@trustedmedia.nl

DenD verloot 3 giftboxen van Wasgeluk. Ga naar DenD.nl/winnen om kans te maken.
Ken jij het geheim van écht frisse was? Ontdek de wasparfum van Wasgeluk: dé natuurlijke geurboost die je wasgoed onweerstaanbaar laat ruiken. Een klein scheutje en je was geurt wekenlang heerlijk fris. En het beste? Geen vettige resten zoals bij wasverzachter, maar puur genot dankzij natuurlijke etherische oliën. Maak jezelf én je was blij! wasgeluk.nl
NIET GEWONNEN? Gebruik de code DITJES10 en ontvang in mei en juni 10% korting op je bestelling.
Laat je samen betoveren door verbluffende zandkunstwerken rondom het thema 750 jaar Amsterdam. Wandel langs indrukwekkende scènes, ontdek verborgen details en beleef de rijke geschiedenis van onze hoofdstad op unieke wijze. Een uitje vol verhalen, verwondering en gezelligheid. zandsculpturen.nl
WINNEN!

WINNEN! DenD geeft 3 exemplaren weg vanDeZaakRoosen. Ga naar DenD.nl/winnen om kans te maken.
De filmische debuutthriller van Frank Cooler is er nu ook als luisterboek. In De Zaak Roosen vertrekt hoofdpersoon Paul Roosen naar een eiland om zijn ingestorte huwelijk en burn-out te verwerken, maar belandt midden in een moordzaak waarin hij zélf de verdachte is. Terwijl hij zijn onschuld probeert te bewijzen, moet hij ook de waarheid over zichzelf onder ogen zien. Spannend en meeslepend tot het eind.

DenD verloot 6X 2 entreetickets voorZandsculpturenin Garderen,inclusiefkoffie metappeltaart.Ganaar DenD.nl/winnen om kans te maken.

Op zoek naar een Moederdagcadeau om te geven of om zelf te tippen aan je kids? De Moederdagcollectie van Melano Jewelry bevat uitsluitend topcadeaus.
Bij een mooie besteding ontvang je ook nog eens een luxe velvet handbag-etui. Dat maakt jouw cadeautje hélémaal af! melano-jewelry.com
WINNEN!DenD doet de Kara kettingmetfleurigeBali Facet steen cadeau. Ga naar DenD.nl/winnen om kans maken.te
In Twist van Colum McCann legt een kabelbreuk het internet van het halve Afrikaanse continent plat. De Ierse journalist Anthony Fennell monstert in Kaapstad aan op een vrachtschip dat datakabels in de diepzee repareert. Fennell is mateloos gefascineerd door de kapitein van het schip, Joseph Conway. Als Conway plotseling verdwenen is, besluit hij naar hem op zoek te gaan. deharmonie.nl


WINNEN!
DenD geeft 5X Twist weg. Ga naar DenD.nl/winnen om kans te maken.
WINNEN! DenDverloot5X 2 entreekaarten voor het Oude Ambachten &SpeelgoedMuseum. Ga naar winnenDenD.nl/ om kans te maken.
Duik in het verleden in het Oude Ambachten & Speelgoed Museum in Terschuur (Veluwe). Met maar liefst 160 oude ambachten waan je je écht even terug in vervlogen tijden. Extra bijzonder: de collectie staat niet achter glas. Je kijkt je ogen uit én komt tijd tekort in dit grote en unieke museum. ambachtenmuseum.nl





























Carbonell is de nummer 1 olijfolie van Spanje en verrijkt al sinds 1866 de keukens van gezinnen over de hele wereld met olijfolie van hoge kwaliteit. Voor bakken en braden kies je voor Traditioneel of Mild.

















*m.u.v. halfvolle melk 2,5L en Boeren Karnemelk 1L LEES MEER OVER HET KEURMERK EN DE VOORWAARDEN


Melkunie Melk en Karnemelk* hebben voortaan het onafhankelijke Beter voor Natuur & Boer keurmerk. Dat is een van de voorbeelden van hoe we stapje voor stapje verbeteren. En dat smaakt naar meer. Lees meer over al onze initiatieven op melkunie.nl/zuivel/datsmaaktnaarmeer















Nederland barst van de doorzetters, slimmeriken en snuggere landgenoten. Dankzij deze geweldenaren staat ons land in de top van de meest welvarende landen ter wereld. Met dank aan ondernemers, wetenschappers en bestuurders met een vooruitziende blik. Het goede nieuws is: een nieuwe generatie talentvolle Nederlanders staat weer klaar. Geweldige talenten die ervoor gaan zorgen dat Nederland geschiedenis blijft schrijven. In de wetenschap, cultuur, sport en het bedrijfsleven. Ditjes & Datjes presenteert de top-25 van deze talenten.
Succes komt niet aanwaaien.
Talent krijg je van je ouders mee, maar daarna begint het pas. Jarenlang studeren, trainen, opofferingen, het hoort er allemaal bij voordat je over de drempel van succes stapt. Bovendien is er een flinke dosis lef nodig om je uiteindelijk te wentelen in het succes. Veel miljardairs hebben nauwelijks een opleiding genoten, maar
MODEL
Kreeg op haar elfde al een eigen reality-serie. Summer veroverde vanuit een Rotterdamse achterstandswijk de wereld. Het model is hoogbegaafd en ontwikkelt zich als actrice. Summer zal het pad van Doutzen Kroes willen

hun zakelijk instinct, hard werken in combinatie met het durven nemen van risico’s, bracht hen de rijkdom.
Maar de maatstaf is niet alleen geld. Het kan ook een wetenschappelijke ontdekking zijn die de wereld verovert, zoals AI of nieuwe medicijnen die voor een doorbraak zorgen in de strijd tegen de ziektes kanker en alzheimer. De gouden

plak van Sifan Hassan op de Olympische Spelen van Parijs was ook een droom die uitkwam. Ondernemer Jitse Groen, oprichter van thuisbezorgd.nl, zag een gat in de bezorgmarkt van maaltijden, zoals de familie Van der Valk ooit ‘het buiten de deur eten’ voor een schappelijke prijs introduceerde in Nederland. Onze DenD-lijst van 25 Nederlandse jonge talenten is een heuse

volgen. Ze werkte al voor grote modemerken als Tommy Hilfiger en Guess.


WINNA CAPTAI
Deze ‘Sjor vrienden heeft he directe Tokay eretit





voorgangers hebben de absolute top bereikt. Ondanks zijn dyslexie ziet Tokaya een rol weggelegd voor menselijk leiderschap. en andswijk de Het egaafd elt ummer ad van n
Deze ‘Sjors’, zoals hij door vrienden wordt genoemd, heeft het geschopt tot Philipsdirecteur beademingsmaskers. Tokaya veroverde ook de eretitel Young Captain van Nederland. Veel van zijn




Ned h bb d b l t t








ontdekkingsreis. Want de meesten op de lijst kennen we nog niet. Deze talenten zitten niet elke avond aan de talkshowtafels. We lezen vrijwel nooit iets over hen in de krant.

De meesten buffelen in anonimiteit. Tot de doorbraak volgt, prijzen worden gewonnen en hun talent soms wereldwijd wordt erkend. Er zijn natuurlijk ook uitzonderingen, zoals Justin Kluivert (zoon van...) die voor het oog van de camera’s zijn voetbaltalent aan de dag legt.











WISKUNDE-GENIE
Velen huiveren voor het gevreesde vak wiskunde, maar Naïm Hofstede uit het Friese Makkum heeft al twee keer de Nederlandse Wiskunde Olympiade gewonnen en behaalde ook een podiumplaats tijdens de Internationale Wiskunde Olympiade. Opmerkelijk is dat Naïm thuisonderwijs volgt en nog nooit fysiek naar school is gegaan. ➜


Voetbaltalent en zoon van oud-voetballer Patrick Kluivert. Justin heeft indruk gemaakt met zijn voetbalkwaliteiten en speelde o.a. bij Ajax, Nice, Roma en nu dan bij het Britse Bournemouth, waar hij wekelijks 80.000 Britse ponden verdient. Grote clubs, zoals Bayern München en Real Madrid, hebben hun belangstelling getoond voor Justin, die staat voor alle Nederlandse talenten op de velden.





ONTWERPER
Duran is één van de grootste talenten van Nederland op modegebied. Waardig opvolger van de generatie Frans Molenaar, Frank Govers Edgar Vos. Hij staat bekend om het gebruik van gebruikte materialen. Lantink maakte voor een clip van zangeres Janelle Monáe vaginabroeken, die viraal gingen. Billie Eilish draagt ook zijn ontwerpen. Geen luxe, wel speels en innovatief. In 2024 kreeg Lantink de Karl Lagerfeld Prize.


NEW SCIENTIST WETENSCHAPSTALENT 2023
Een knappe kop die bekend staat om haar baanbrekende werk op het gebied van 3D-beeldvorming en menselijke ontwikkeling. Ze heeft diverse prijzen gewonnen voor haar onderzoek naar embryonale en foetale ontwikkelingen. De Bakker is een inspiratiebron voor jonge wetenschappers. „Mijn doel is om menselijke ontwikkeling begrijpelijker te maken”, aldus Bernadette de Bakker.










( 26 )
LERARES VAN HET JAAR
LER A

2024
Deze Tuind het ga onder gestel te stom maats Van d ger van vers en k van een oeken, ijn atief. e





was. Later kwam de Bredanaar met NovaHost, dat al snel weer werd doorverkocht en ontstond Mollie en weer later kwam het succesvolle Messagebird. Mol heeft geen relevante opleiding gevolgd, maar ontdekte dat je vanuit de slaapkamer ondernemingen kunt opbouwen.














Deze Utrechtse juf uit de wijk Tuindorp is zwaar gemotiveerd als het gaat om kansengelijkheid in het onderwijs. Ze heeft zich ten doel gesteld om haar leerlingen klaar te stomen voor een mooie, diverse maatschappij, schreef de jury over Van der Linden. Roos zegt dat leerlingen zekerder worden door haar aanpak. „Ze ervaren meer succesmomenten, wat weer zorgt voor meer motivatie”, aldus de lerares van het jaar.







Bereikte zonder hulp van vermogende ouders de status van miljardair. Bedenker van het computerspelletje MacSnake toen vijftienjarige het internet aan het ontdekken
der van vermos de status van edenker van rspelletje en Mol als het internet ekken
Dit ‘wonderkind’ uit Vlaardingen kan met twee handen tegelijkertijd, ondersteboven, vier portretten tegelijk maken. Rajacenna is een begaafd kunstenares, die bekend staat om haar hyperrealistische tekeningen. Ze is autodidact en begon op jonge leeftijd met tekenen. Haar werk is wereldwijd tentoongesteld en ze heeft een grote online aanhang. Haar werk wordt internationaal erkend en haar schilderijen verkopen voor bedragen tussen de €6.000 en €12.000.
met teken tento een grote
Haar wo erkend en haa voo
€6.000 en







Actrice Claire Bender, afgestudeerd aan de Toneelacademie Maastricht, vertolkte de glansrol van Virrie Cohen in de serie De Joodse Raad. Bender is een van de meest talentvolle actrices van dit moment. Bekend ook van het absurde Rundfunk, de serie Morten en comedy-drama Dertigers. De speech van Bender tijdens de uitreiking van de Televizier-Ring Impact maakte veel indruk op publiek en kijkers. t


VOETBALSTER
Speelde bij FC Barcelona en won in haar eerste seizoen de Champions League, ze ontving de Johan Cruijff Award voor voetbaltalent van het jaar en staat nu in de aanval van PSV. Esmee is één van de grootste talenten van Nederland en staat ook in het Oranje van bondscoach
Andries Jonker. Haar vroege stap naar het buitenland kwam vooral voort uit de wil om een betere voetbalster te worden.
KAMERLID VOLT
Ze is afkomstig uit AmsterdamZuidoost en heeft daarna veel van de wereld gezien. Koekkoek legt in de debatten in de Tweede Kamer slimheid en vastberadenheid aan de dag. Ze dwingt respect af. Marieke kwam bij de vorige verkiezingen met voorkeurstemmen in de Kamer. Bij terugkeer na haar zwangerschap werd door Kamervoorzitter Martin Bosma de grap ‘The return of the Koekkoek’ gemaakt.


De landelijke voorzitter van de JOVD is voor de duivel niet bang. Ondanks zijn jonge leeftijd maakt hij indruk binnen de VVD, omdat de kritische geluiden een goede voedingsgrond vinden. Bresser wordt inmiddels ook gevraagd om commentaar te geven op actuele kwesties, maar werd ook geprezen als panellid bij de quiz Kiespijn. Getipt als mogelijk VVD-leider in de toekomst.



Het idee achter Momo Medical kwam tijdens zijn studieperiode Elektrotechniek in Delft. Doel was om de werkdruk in de zorg te verlagen door middel van techniek. Via de Momo BedSense App, die in contact staat met een sensor onder het matras van een patiënt in verpleeghuis, kunnen zorgmedewerkers in een oogopslag zien wie zorg nodig heeft. Het voorkomt onnodige nachtelijke rondes. Gravemaker verovert de wereld met deze App. ‘Minder praten, meer bouwen’, is het motto van Gravemaker, die inmiddels ook een veelgevraagd spreker is.




KROONPRINSES

De oudste dochter van koning Willem-Alexander en koningin Máxima is de troonopvolger. De kroonprinses studeert nog, maar prepareert zich stap voor stap voor op haar toekomstige rol als koningin. Onlangs doopte ze nog een Nederlands oorlogsschip in Vlissingen. Amalia is lid van de Raad van State en maakte al haar opwachting tijdens de troonrede op Prinsjesdag. Verwacht wordt ze na haar studie een opleidingstraject ingaat, waaronder ook een stageperiode bij het Ministerie van Defensie. ➜

DANSERES
Nova Valkenhoff, geboren in Leiden, studeerde in 2021 af bij het Nederlands Dans Theater en kreeg meteen een contract aangeboden als fulltime danseres. Ze ontwikkelt zich tot een van de grote danseressen van Nederland die alleen maar meer uitdagingen zoekt. „We kunnen het altijd beter doen of harder werken”, aldus



ggpj 4 g , dus
Nova, die blij is dat ze professioneel danser kon worden. De jury van de Stichting Dansersfonds ’79 was lovend over Nova, die samen met danseres Demi Bawon de Aanmoedigingsprijs 2024 ontving.











Prinses Beatrix reikt de Aanmoedigingsprijs uit aan Nova (tweede van rechts) en Demi (rechts).
SCHRIJFSTER
Eind 2024 werd El Khannoussi door De Volkskrant uitgeroepen tot hét literatuurtalent van het jaar 2025. Haar roman Oroppa werd geprezen als ‘een kolkende zee van verhalen, met voelbaar plezier opgedist’, waarmee ze ‘de letteren binnen denderde’.









Emma Kok is een jonge Nederlandse zangeres, die bekend werd door het winnen van The Voice Kids Ook concertleider André Rieu ontdekte de jonge Limburgse. Emma bracht het Vrijthof in beroering, tot tranen toe. Ze mocht mee op wereldtournees van Rieu, ondanks haar zware ziekte. Ze lijdt aan een maagverlamming, ook wel gastroparese genoemd. Dinsdag 21 oktober staat Emma in het Concertgebouw. Ze zingt daar ongetwijfeld het Franse chansonVoilà waar ze bekendheid mee verwierf. j vertegen ze Stu NL FI W i w p s to







Safae, geboren in het Marokkaanse Tanger, werkt nu aan haar promotieonderzoek over politieke filosofie.
Ze is lid van Shorttrack Brabant in Den Bosch en heeft zich de afgelopen seizoenen sterk ontwikkeld. In januari 2025 vertegenwoordigde ze Student Team NL op de FISU Wereld Winterspelen in Turijn, waar ze haar passie voor shorttrack toonde.






Ons grootste vrouwelijk schaaktalent dat op jonge leeftijd al grote successen heeft behaald. Ze wordt al de Nederlandse The Queen's Gambit genoemd, verwijzend naar de hoofdrolspeelster in de succesvolle schaakfilm. Op haar veertiende was ze Europees kampioen en ze kreeg drie jaar geleden de titel internationaal meester. Eline heeft verschillende nationale en internationale toernooien gewonnen.


CABARETIER
Amsterdammer met Nederlands-Poolse wortels speelt voor volle zalen in heel Nederland. Hoebe is bekend geworden door zijn snelle grappen en doordat delen van optredens online zijn te volgen. Hij betrekt zijn publiek bij de voorstelling. Maakt dan grappen zonder enige schaamte. Zeer geestig. Kor kan zo maar de nieuwe Youp worden.


Natuurlijk droomt dit Nederlandse racetalent, met Chinese wortels maar geadopteerd in Nederland, van een racecarrière zoals Max Verstappen die heeft bereikt. Voorlopig zit Zheng nog in een kart (een kleine racewagen). Hij werd al een keer Nederlands kampioen, terwijl zijn peetvader, die Zheng adoreert, nu als monteur optreedt. Kuyf is ook erg goed in het online besturen van een racewagen.

Mackenbach won in 2009 het Junior Eurovisiesongfestival met het liedje ‘Click clack’ en is nu kernfysicus; verbonden aan de TU Eindhoven. In 2023 promoveerde Ralph op onderzoek naar plasmadynamica. Ralph stelt dat het verleidelijk was om voor de showbizz te kiezen, maar dat hij voluit gaat voor de uitdagingen van de wetenschap.
Dit Nederlandse talent staat bekend om zijn onderzoek op het gebied van neurowetenschappen. Hij heeft verschillende prijzen gewonnen
rtels k




Marco Helsloot kookt sinds twee jaar bij sterrestaurant Merlet in Schoorl. De Volendammer werd tot de Jonge Chef van het Jaar 2025 gekozen. Al 26 jaar heeft Merlet een Michelin-ster, voor Helsloot is een belangrijke taak weggelegd om die ster ook te behouden. De jonge chef bulkt van het kokstalent. ‘Zijn kookstijl’, zo schrijft het horeca platform Entree, ‘heeft een klassiek Franse basis, gecombineerd met subtiele Aziatische invloeden’.

voor zijn werk. Zijn onderzoek heeft bijgedragen aan een beter begrip van het menselijk brein. Zijn masterthesis werd geprezen door Nobelprijswinnaar Frank Wilczek. Robin kreeg op school een vmbo-advies vanwege zijn dyslexie. Dol op Rubikskubussen. ■
voor werk. Z van Zijn geprezen winna Rob ee va dy R

CHOOSE MOUNTAIN-MADE MINERALS











Zondag 11 mei is het Moederdag. De dag om mama extra in het zonnetje te zetten en te verwennen met een ontbijt op bed of een ander mooi cadeau. Moederdag wordt in veel landen gevierd, maar niet overal op dezelfde dag. Zo zetten Spaanse kinderen hun madre op 4 mei in het zonnetje en hebben de Engelse kids hun mother al op 30 maart een cadeautje gegeven. Is het je trouwens wel eens opgevallen dat het woord voor ‘moeder’ in bijna alle talen begint met een M? Mutter (Duits), mother(Engels), madre(Spaans), matka(Pools)…
Naast Moederdag vieren we in Nederland ook Vaderdag. Maar wist je dat sinds 2004 ook Opa- en Omadag bestaat, officieel op 4 juni? Deze ‘Grandparents Day’ is in 1978 in het leven geroepen door de Amerikaanse Ouderenrechtenactiviste
Marian McQuade Om eenzame ouderen in contact te brengen met kinderen die wel een (extra) opa of oma konden gebruiken en om ervoor te zorgen dat jongeren meer respect kregen voor ouderen.
oor de Amerikaanse activiste de. deren gen pa r















Geven we mama een lekkere geur of iets moois voor in huis? Met de Minéral parfumsticks van Maison Berger geef je beide. Of je nu gaat voor een frisse watergeur of meer houdt van bloemen, elke variant heeft een elegante artdeco uitstraling. w een lekke moo parfums
Maison B beide gaat voor watergeu houdt van var een eleg deco uit












Bloemen gekregen voor Moederdag? Ze komen mooi tot hun recht in een van de twee zwierige keramieken vaasjes van H&M. Ook zonder bloemen is deze vazenset een decoratieve aanwinst voor je woonkamer. Goed


























Met een sieraad als Moederdagcadeau zit je altijd goed. Neem nou deze zilveren schakelarmband van Pandora. Op zich al een beauty, maar door er bedels aan te hangen, maak je de armband persoonlijk en daarmee nog mooier.










Deze grof gebreide plaid van Loberon houdt je comfortabel warm als het ’s avonds wat killer wordt en is tegelijkertijd een stijlvol en gezellig accessoire. De knusse, zachte deken is gemaakt van puur katoen.



De wijzerplaat van de Pink Petal Promise van Swatch is geïnspireerd op de camellia, de gracieuze Japanse roos die liefde en perfectie uitstraalt. Net als mama. De zilverkleurige wijzers hebben een glow-in-the-darkeffect.
Van baby Pink l
Van dromerig roze en pistache-groen tot sprankelend babyblauw… Met deze prachtige pasteltinten van Pink Gellac lakt mama haar nagels in de mooiste lentekleuren. De Blooming Meadows Collectie is verpakt in een bloemige geschenkdoos.




Nicole Kidman in een tulpenveld, ergens diep in het Amerikaanse Midwesten. Holland is geen doorsnee thriller, maar eentje waar de bloembollen bloeien terwijl het wantrouwen groeit.
Nicole Kidman op klompen, in Volendamse klederdracht met een witte kap en kleurrijke rok. Zo zie je haar in haar nieuwste film Holland (Prime Video). Opgelet: dit is niet het Holland van motregen, de ochtendspits en multiculti wijken. Dit is is het plaatsje Holland in Michigan. Een Amerikaans stadje dat zo zijn best doet op Nederland te lijken dat je er bijna de haringlucht bij fantaseert. Gesticht in 1847 door calvinistische separatisten en inmiddels uitgegroeid tot een keurig mini-Nederland: compleet met tulpenfestivals, windmolens en Delfsblauw.
Clichés
Holland speelt zich dan wel af in de VS, maar het verhaal druipt van de oer-Hollandse clichés. In de ogen van Hollywood hobbelen onze kinderen nog steeds op klompen naar school, happen we haring in klederdracht en lijkt het jaar 1890 nooit opgehouden. Overigens is Nederland niet het enige land
In de ogen van Hollywood hobbelen onze kinderen nog steeds op klompen naar school...



dat in clichés wordt weergegeven. Frankrijk is al snel wijn en minnaars, Engeland staat voor thee en keurige stiltes. En New York? Dat is in Europese films vaak niets meer dan een enorme skyline met een gele taxi. Toch zien sommige recensenten wel door het mooie plaatje heen. Roger Ebert noemt Holland 'een papieren decor', leuk voor een thriller, maar totaal niet geloofwaardig. Variety zag 'een kitsch versie van Nederland' met tulpenvelden tot aan de horizon en molens die nét iets te perfect hun rondjes draaien.
Kidman speelt Nancy Vandergroote, een lerares en voorbeeldige huisvrouw met een ogenschijnlijk perfect leven. Tot ze langzaam begint te vermoeden dat haar man Fred (Matthew Macfadyen) iets voor haar verbergt. Hij is wel erg vaak op zakenreis, reageert kortaf, en ineens voelt alles wat ooit vanzelf ging... verdacht. Net voor het jaarlijkse tulpenfestival broeit er iets onder het keurige oppervlak. Nancy’s wantrouwen groeit. Leidt Fred misschien een dubbelleven?
Is de film nagelbijtend spannend? Nou… niet bepaald. Rotten Tomatoes geeft Holland een schamele 36%, en The Guardian noemt het een 'teleurstellende puinhoop’ met voorspelbare twists en nul spanning. Ook de Volkskrant is niet in de feeststemming: een ‘malle, saai geregisseerde thriller met een teleurstellend scenario’. Alleen de topacteurs houden het nog een beetje overeind. ‘Daarbij: welke Hollywoodfilm heeft nou een soundtrack met liedjes van Ramses Shaffy, Rob de Nijs en Wim Sonneveld?’ Maar goed — niemand draagt een Volendamse kap zó stijlvol tragisch als Nicole. Dat dan weer wel.


Wat heeft Nicol met N zov wél een Ned recent werd geregi onze eigen H kreeg werel reacties. zwa k rs

Nicole Kidman eigenlijk met Nederland? Nou, direct niet zoveel. Maar er is wél een Nederlands lijntje: haar recente hit Babygirl werd geregisseerd door Halina Reijn en kreeg wereldwijd lovende reacties. Misschien dat Nicole sindsdien een zwak heeft voor klompen, kaas en Calvinistische drama’s?
Nicola als een soort Zeeuws meisje.






























Prins Pieter-Christiaan met Jeroen van den Boom bij de herlancering van Radio Noordzee.

Zanger Nielson ziet ook wel brood in Radio Noordzee. g van Radio Noordzee.




Klaar voor een vloedgolf aan Hollandse hits? Radio Noordzee is terug van weggeweest.







Piratenzenders als Mi Amigo, Radio Veronica, Radio Noordzee maakten 50 jaar geleden een onuitwisbare indruk op de jongeren van toen. Met veel bekende dj’s als Ferry Maat, Tom Mulder, Will Luikinga en Tineke de Nooij werden de Hilversumse zenders overklast. Ruim 50 jaar later is Radio Noordzee helemaal terug.
De verrassende doorstart van Noordzee werd gevierd met een openingsfeestje. Prins
Pieter-Christiaan, zelf ook dj, opende de zender terwijl talloze Nederlandse artiesten de herlancering bijwoonden. Want Radio Noordzee gaat uitsluitend en consequent Nederlandstalige muziek uitzenden. 200% puur Hollands is de reclameslogan.
Nederlandstalige muziek is anno 2025 razend populair. Flemming, Yves Berendse, Tino Martin tot aan wonderkind Roxy Dekker,






Nederland krijgt er maar geen genoeg van. Ook Talpa verwacht dat de fans massaal afstemmen op Radio Noordzee. „De reacties van artiesten waren overweldigend na de aankondiging van Radio Noordzee eerder dit jaar”, aldus Dave Minnebo van Talpa Radio. Het Nederlandstalige lied werd decennialang door de Hilversumse zenders genegeerd. Radio Noordzee zal echter moeten concurreren met 100%NL en RadioNL.
Hitzangers Marco Schuitmaker, Mart Hoogkamer, Sven Versteeg, 3JS, Jeroen van den Boom en Wesley Bronkhorst vierden het feestje mee. Marlayne Sahupala, ooit deelnemer aan het Eurovisiesongfestival en bekend van Hart van Nederland, presenteert het ochtendprogramma op Radio Noordzee tussen 10.00 en 12.00 uur. ■
Het oude zendschip Mebo II van radiopiraat Radio Noordzee.

DenD welkom op uw party?
Stuur uw uitnodiging naar: redactie@dend.nl Stu

Zolang je in Nederland een beetje op tijd bent, je werk doet, en zelfs met een grijns op je gezicht doorfietst als je net door een vrachtwagen bent aangereden, komt het allemaal wel goed. We houden van mensen die zich niet aanstellen. Uitgerekend Gerard Joling blijkt hiervan de perfecte belichaming. Jaren geleden stond ik mezelf in een stampvolle metro te vervloeken omdat ik niet even had gecheckt of er die avond iets groots gepland stond in de Johan Cruijff ArenA. Terwijl ik bijna van mijn stokje ging door de geur van zweet, en duizelig werd van de roodwitblauwe hoedjes, dacht ik: wat geestig dat deze mensen een uur geleden nog onder een systeemplafond automaatkoffie uit een kartonnen bekertje zaten weg te werken, en nu als een stel halvegaren onderweg zijn naar De Toppers.
Dankzij
Only Joling weten we nu echter beter. Ik had verwacht dat de serie een spoor van pauwenveren en pailletten in mijn televisie zou branden. In plaats daarvan zien we een man die het belangrijk vindt dat mensen hard werken en zich aan hun afspraken houden, oog heeft voor zijn omgeving en zich er enorm aan stoort als
anderen die waarden níét uitdragen. Alleen trekt hij ‘s avonds een verenpak van zolder om ergens in het land de tent af te breken.
Dat Joling serieus is in zijn principes, wordt pijnlijk duidelijk als zijn zwager Sjoerd in de serie op het allerlaatste moment het vijftigjarig huwelijksfeest met Jolings zus Gerdi afzegt. Het onbegrip bij de entertainer druipt van de tv, en je voelt het mee: waar Sjoerd afbelt met een kuchje waarvoor de huisarts vermoedelijk niet eens paracetamol voorschrijft, zou de zanger zelfs met een gebroken rug nog Ticket to the Tropics inzetten. Afspraak is nu eenmaal afspraak. En dat is dan nog ‘slechts’ werk, terwijl dat feest over iets groters gaat. Oké, misschien niet voor Sjoerd. Maar ongetwijfeld wel voor Gerdi, en daarom ook voor Joling. Van iemand die geboren lijkt in een glitterpak, zou je toch eigenlijk de diepe overtuiging verwachten dat de wereld om hem draait en om hem alleen.
D ie mist Joling. Hij voelt zich ellendig voor zijn zus als alle gasten naar huis worden gestuurd. Hij neemt zijn overburen mee op sleeptouw tijdens

Joling weet wat telt: op tijd komen, je was draaien, en nooit je zus laten zitten.



Koningsdag. In zijn geboorteplaats Schagen kent hij alles en iedereen. Hij weet wanneer iets landt. En hij weet bij wie.
Grof
Afgelopen najaar maakte ik het zelf mee. Van de andere kant van de bar schalde hij ineens door een Amsterdamse kroeg: een grof, absurd rijmpje over iemand die ondanks haar talent hoog in mijn irritatiezone zit. Geen twijfel mogelijk: dit was voor mijn oren bedoeld. Toen ik opkeek, zag ik een grijnzende Gerard. Geen woorden, geen uitleg. Hij had mijn irritatie onthouden en liet op precies het juiste moment blijken: Wij begrijpen elkaar, toch? De grap is helaas onherhaalbaar. Niet omdat ik
Halina Reijn wil beschermen, maar omdat ik geen zin heb in nóg een therapeutisch interview met haar.
Gordon
H et succes van Only Joling heeft één nadeel: het contrast met Gordon maakt hen als duo ongeloofwaardig. Waren de twee voorheen actief als de spreekwoordelijke firma instabiel & explosief, inmiddels weten we beter. Joling werkt al veertig jaar samen met z’n ex, waarvan de laatste twaalf jaar met diens nieuwe partner. De huishoudster is al 25 jaar



in dienst. Als hij gaat slapen, zet hij trouw elke dag het alarm erop. Intussen brandt Gordon op drie continenten door vriendschappen alsof het koffiecupjes zijn: na gebruik direct weggooien, en dan luid klagen over de nasmaak. Joling & Gordon Over De Vloer wás helemaal geen programma was van gelijken. Psychiater Joling nam simpelweg zijn charmant explosieve patiënt Gordon op sleeptouw.
Waar
Gordon nog altijd hunkert naar applaus, doe je Gerard geen groter plezier dan wanneer het licht uit is, de wasmachine draait en niemand op z’n planten trapt. Hij is waarschijnlijk de enige persoon in dit land die Calvinistisch plichtsbesef zo consistent weet te combineren met een paillettenbroek. En dus mogen we hem best erkennen voor wat hij is: onze officieuze Vader des Vaderlands, maar dan wel met foundation en een knaloranje boa om zijn nek. ■
































































Kunst & interieur










CREËER SFEER MET WANDDECORATIE OP KLEUR
Kleur heeft een enorme invloed op de sfeer in huis. Het kiezen van de juiste tinten kan een ruimte warm, fris of juist kalm laten aanvoelen. Wanddecoratie speelt hierin een belangrijke rol: het geeft karakter aan je interieur en zorgt voor balans en harmonie. Door kleuren en decoratie bewust af te stemmen, ontstaat er een sfeer in huis waardoor jij je geweldig voelt!
EEN ZONNETJE IN HUIS
Een kleur die momenteel veel aandacht krijgt is botergeel. Deze zachte, warme tint brengt zonlicht en vrolijkheid in huis. Botergeel is veelzijdig en combineert prachtig met neutrale kleuren zoals crème, beige en wit, maar ook met aardetinten en warme bruintinten. Het gebruik van wanddecoratie in deze trendkleur, zoals schilderijen, posters of textiel, zorgt voor een subtiele maar opvallende accentkleur.
Kleuren in huis veranderen vaak met de seizoenen. In de lente en zomer zien we veel frisse en levendige kleuren, zoals geel, groen en pastelkleuren. In de herfst en winter komen juist warme, diepe tinten zoals okergeel, roestbruin en donkergroen naar voren. Wanddecoratie kan hierop inspelen door per seizoen aan te passen, bijvoorbeeld door het wisselen van kunstwerken, fotolijsten of wandkleden.
TIP: DURF TE EXPERIMENTEREN
Durf te spelen met kleur! Hang een opvallend kunstwerk op dat direct de aandacht trekt, of geef een hele wand een gedurfde kleur en combineer dit juist met een subtieler kunstwerk. Voeg kleur toe aan je interieur en creëer een unieke sfeer. Zo maak je van je huis een plek die blijft verrassen en inspireren. ■





Geïnspireerd om meer kleur
toe te voegen aan je interieur?
Quint Art helpt je graag! Je maakt nu kans op deze prachtige kunstprint ter waarde van 50 euro!
Meedoen? Bezoek snel onze website en meld je aan voor onze nieuwsbrief.










KIM VERMEER (QUINT ART)






MAKKELIJK BESTELD, SNEL GELEVERD Jouw kunstwerk in no-time thuis.
MOOIE KUNSTPRINTS zonder luxe prijskaartjes.
100% KWALITEIT Verkrijgbaar op meer dan 10 verschillende materialen!




ALTIJD DE LAAGSTE PRIJS
ONTDEK ONLINE! Scan de QR-code





EMILE BODE
Klustips & tricks Huishoudbode
s ode







IDe een heeft een schuur vol gereedschap, de ander bijna niets omdat hij of zij twee linkerhanden heeft, alles laat opknappen of gewoon geluk heeft dat er zelden iets stukgaat. Maar sommige hulpmiddelen zijn in elk huishouden onmisbaar.
k ben zelf niet heel handig, maar toch heb ik laatst een dure teakhouten ligstoel gerepareerd met houtlijm en flinke klemmen. Die stoel is al 25 jaar oud en vooral jongeren zeggen dan vaak: ‘Gooi toch weg, man. Koop iets nieuws!’ Maar ja, ik doe mijn vrouw, na 46½ jaar huwelijk, toch ook
niet weg? Of zij mij. Dat kost me trouwens een vermogen.
Klusje
Als ik u vraag wat de drie meest onmisbare hulpmiddelen in en rond het huis zijn, weet u het waarschijnlijk niet. Terwijl u ze vast gewoon in huis heeft. Volgens het Algemeen Dagblad

zijn tiewraps, ducttape en WD-40 genoeg om vrijwel elk klusje op te lossen. Ik heb een grote hoeveelheid tiewraps in de schuur, in alle maten. Ik koop altijd de kleurloze en ze komen vaak tevoorschijn om planten vast te zetten. En natuurlijk om bedrading op te binden of spullen op te hangen. Het is ook een
goedkope sleutelhanger. Je kunt er een spotgoedkoop douchescherm mee maken en er zelfs bellen mee blazen. U moet de tiewraps alleen niet laten slingeren. Onze oudste kleinzoon heeft er jaren geleden eentje van mij meegenomen bond er de polsen van een vriendje mee vast. Die begon te huilen.
Ducttape - heel veel mensen zeggen Ducktape - is ideaal voor noodreparaties en om kleine lekken en scheuren te repareren. Het is bovendien waterafstotend. Veel mensen denken dat de naam daarvan komt, omdat het water afstoot, net als de rug van een

Ducttape is onmisbaar.
eend (duck). In werkelijkheid is het vernoemd naar ‘ducts’, de luchtkanalen waarvoor het oorspronkelijk werd gebruikt.
En dan WD-40, het bekende blauwe spuitbusje met synthetische olie. Het smeert, reinigt en beschermt, maar is vooral onmisbaar om verroeste moeren, schroeven en bouten los te krijgen. Ook ideaal tegen piepende scharnieren. Daarnaast laat het een beschermlaag achter die vocht weert en roestvorming tegengaat. Heel wat fans overdrijven de mogelijkheden van WD-40. Zo zou je er een leren jas mee kunnen impregneren. Nou, ik dacht het niet. Voor diverse klussen zijn fietskettingspray, siliconenspray, of contactspray beter. Uiteraard heb ik ze alle drie in huis. Alleen geen smeerolie van het merk WD-40, maar wel de goedkopere multispray.

Wie zich in Zeeland verveelt, heeft dat aan zichzelf te wijten.


Ik ben tientallen jaren nauwelijks in Zeeland geweest. Op jonge leeftijd bezochten mijn vrouw en ik regelmatig een schoolvriend in Zeeland. Maar het was altijd winter, koud en de wegen waren glad. Ik dacht: ‘Hier wil ik nog niet begraven worden!’
Jarenlang bleef Zeeland links liggen, maar vorig jaar brachten we er met de kinderen en kleinkinderen toch een lang weekend door. We hadden gelukkig geweldig weer. We maakten uitstapjes naar Veere, Domburg en Middelburg. We slenterden over het strand, aten lekker en gingen winkelen. We verbleven overigens in een geweldige vakantiewoning in Colijnsplaat op NoordBeveland. Natuurlijk gingen we ook een ochtend over de Zeelandbrug naar Zierikzee,
en daarmee stonden we op Schouwen-Duiveland. Zierikzee heeft de gezelligste winkeltjes. Vooral op het gebied van sieraden, ambachten, kleding en interieuraccessoires is er veel te ontdekken. En je wandelt hier heerlijk door de pittoreske straatjes. Wat je niet mag missen op Walcheren? Het stadhuis van Middelburg aan de Markt natuurlijk. De oudste delen dateren uit de vijftiende eeuw. En Deltapark Neeltje Jans is zeker een omweg waard.
Mijn excuses
Je kunt ook gewoon heerlijk struinen door de drukbezochte toeristenstadjes. De winkels zijn in de meeste toeristencentra ook op zondag open. Ik moet nederig mijn excuses maken dat ik Zeeland zo lang heb gemeden. Dit bezoek was relaxt en gezellig - we komen hier zeker nog eens terug.













Heerlijk luchtig... de toetjes van




n de
































Als donkere basterdsuiker hard is geworden, heeft Maria Lips een simpel trucje: ze legt de suiker in een afgesloten bakje met de schil van een mandarijn of sinaasappel. Binnen no time is de suiker weer zacht. Vergeet alleen niet de schil op tijd te verversen!

Mevrouw Doedens vraagt of witte vitrage na het wassen in de droger kan. Ik zou dat nooit doen, en mijn vrouw en ik zijn ervaringsdeskundigen. In de woonkamer hebben wij zes ramen met vitrage. Het schoonmaken is een snelle, welhaast militaire operatie. Eerst haal ik ze eraf, de haken gaan in een pantykousje, en dan draaien ze op 30 graden in de wasmachine. Daarna hang ik ze nat weer op. Niet in de droger, want dan krijg je juist meer kreuk. Bovendien drogen ze, nat opgehangen, verrassend snel.
Een bijzondere tip van mevrouw Hinke Dijkstra.

Zij hoorde ooit van een oude vrouw dat de aarde van een molshoop uitstekende bloemenaarde is. „Elke keer als ik die bulten zie, denk ik daaraan, terwijl ik toch gewoon tuinaarde koop.” In zekere zin had die oude dame gelijk. Mollen woelen de grond door, waardoor de klei bij ons makkelijker hanteerbaar wordt. Ook ideaal om bloemen in te planten.
Het ongedierteseizoen breekt zo langzamerhand aan. Denk dan aan deze bekende tip: hang een doorzichtig plastic (boterham)zakje, voor de helft gevuld met water, bij de voordeur op en je hebt geen last van vliegen in huis.
Het schijnt dat de zakjes het licht vangen en op een bepaalde manier reflecteren, waardoor vliegen gedesoriënteerd raken en rechtsomkeert maken. Waarom andere insecten hier niet intrappen, is mij een raadsel. Wij hebben gelukkig overal horren en een ouderwets kralengordijn voor de voordeur. Vrijwel geen vlieg of ander ongedierte waagt zich naar binnen.

je eoubewee insmeren met
Af en toe krijg ik een mail van lezers die beweren dat wespen het bovenste laagje van onbewerkt hout van hardhouten tuinmeubelen wegknagen. Dat klopt. Wespen knagen ook aan schuttingen, riet en schors. Ze voegen speeksel toe aan het geknaagde hout en maken zo een soort papier, dat ze gebruiken voor hun nest of raat. Om de wespen te verjagen, kun je het hout bewerken met houtolie of de plekken insmeren met groene zeep.





O m met



Ook helpt het om de meubelen te wassen met een mengsel van water en veel ammoniak. Of zet een schaaltje lauw water neer met drie kruidnagels; dat schijnt ze ook op afstand te houden. Zelf heb ik nooit actie ondernomen. Voordat de wespen onze buitentafel hebben opgegeten, zijn we een paar eeuwen verder. ■


Of zet e water neer met drie k
Heeft u een geweldige tip of een leuk verhaal?
Mail naar info@emilebode.nl en maak kans op een waardebon van €25. Vergeet niet uw adresgegevens te vermelden.





































































De tuin staat volop in bloei, maar een paar zonnige dagen en je hortensia’s hangen er zielig bij. Hoe houd je alles fris zonder dagelijks met een tuinslang in de weer te zijn? Slim bewateren is de truc. Sproei vroeg in de ochtend of laat in de avond, zodat het water niet direct verdampt. Geef water direct bij de wortels en niet over de bladeren. Een regenton is een slimme investering en een laag mulch helpt de grond langer vocht vast te houden. Denk ook na over planten die minder dorstig zijn. Lavendel, tijm en salie kunnen prima tegen een beetje droogte.
En mocht je toch sproeien: liever één keer per week een flinke plens dan elke dag een beetje. Zo worden planten gestimuleerd om dieper te wortelen, wat ze beter bestand maakt tegen droogte. Bovendien is een beetje dorst niet altijd slecht; veel vaste planten en struiken worden er juist sterker door. Een goede wortelstructuur betekent dat ze minder afhankelijk worden van jouw gieter en dat ze zich beter kunnen weren tegen een hittegolf.


Droom je van een zomerse tuin waar je zonder veel gedoe van kunt genieten? Met de juiste planten haal je moeiteloos de sfeer van Zuid-Europa naar je eigen achtertuin of balkon. Lavendel, rozemarijn en tijm zijn niet alleen sterk en makkelijk in onderhoud, maar trekken ook bijen en vlinders aan. Voor een echt mediterrane uitstraling doen terracottapotten en een grindpad wonderen. En als je de ruimte hebt, zet dan een vijgenboom of olijfboom neer. Die kunnen hier prima groeien, zolang ze veel zon en een beschut plekje



krijgen. Extra tip: zet geurige kruiden zoals basilicum, munt, oregano of citroentijm in de zon. Zo ruikt je tuin heerlijk en heb je altijd verse kruiden bij de hand voor in de keuken.





1

2 ZOMERBOLLEN PLANTEN
Nu is de tijd om dahlia’s en gladiolen de grond in te stoppen.


MUGGEN-PROOF





Plant citroenmelisse, lavendel en munt; muggen hebben er een hekel aan, jij geniet van de geur.




3

GAZONONDERHOUD
Niet te kort maaien! Laat het gras iets langer, zo droogt het minder snel uit en blijft het groener. G zo








Als er één bloem is die in het voorjaar alle aandacht opeist, is het de Itoh-pioen. Dit juweeltje, een kruising tussen de gewone pioenroos en de boompioen, combineert het beste van beide werelden: de bloemenpracht van een klassieke pioen en de stevigheid van een boompioen.
Waar de klassieke pioen het vaak na twee weken voor gezien houdt, bloeit de Itoh-pioen (Paeonia × Itoh) vrolijk door tot in de zomer. Dit komt doordat hij meerdere knoppen per steel heeft, waardoor je wekenlang van een nieuwe bloemenpracht kunt genieten. Bescheiden is hij allerminst: sommige bloemen worden zo groot als een ontbijtbord.
Gemak

tot gewone pioenen, die door hun zware bloemen vaak ondersteund moeten worden, heeft de Itohpioen stevige, rechtopstaande stelen. Geen omvallende bloemen na een regenbui dus. Bovendien is hij volledig winterhard en vraagt hij nauwelijks onderhoud. Even geduld is wel nodig: de eerste jaren groeit hij nog bescheiden, maar eenmaal gevestigd wordt hij elk jaar voller en uitbundiger.
Sommige bloemen worden zo groot als een ontbijtbord
Geel, abrikoos, felroze of diep bordeaux; de kleuren van de Itoh-pioen zijn net zo indrukwekkend als de bloem zelf. Sommige soorten, zoals ‘Bartzella’, veranderen zelfs tijdens de bloei van tint. Niet alleen de bloei is spectaculair, ook het gemak. In tegenstelling
vaste plant, maar daar krijg je een jaarlijks terugkerend spektakel voor terug. Een investering waar je jarenlang plezier van hebt, en waar de bijen en hommels je ook nog eens dankbaar voor zijn.



, r voor zijn. ■


Zet hem op een zonnige plek (minstens zes uur zon per dag), geef hem af en toe water, en verder laat je hem met rust. Snoeien is niet nodig, behalve het weghalen van dode takken in het voorjaar. Ook in een vaas komt de Itohpioen goed tot zijn recht. De stevige stelen en grote bloemen zorgen ervoor dat je extra lang van de bloei kunt genieten, zowel binnen als buiten.
Spektakel
De Itoh-pioen is misschien iets duurder dan een gemiddelde











De Itoh-pioen is vernoemd naar de Japanse kweker Toichi Itoh, die als eerste de gewone pioen en boompioen succesvol wist te kruisen. Omdat deze planten van nature lastig te vermeerderen zijn, duurde het decennia voordat de eerste Itoh-pioenen op de markt kwamen.







Haringhapjes in een heerlijke roomsaus en kerrie saus!






Haring zoals je 'm nog niet kende! Een nieuwe twist op een vertrouwde klassieker.


















Kijk dan op



Er zijn dagen dat je wilt uitpakken in de keuken, maar er zijn ook dagen dat je vooral wilt dat het lijkt alsof je hebt uitgepakt. Deze gerechten vallen in de laatste categorie. Een romige pasta met asperges en gerookte zalm die moeiteloos door kan als ‘speciaal’, en een baguette met avocado, ei en Serranoham die je serveert alsof je een hip lunchzaakje runt.




✔ 300 g verse pasta (tagliatelle)
✔ 200 g gerookte zalmmoot
✔ 200 ml kookroom
✔ 1 rode ui
✔ 500 g groene asperges
✔ 1 bosje lente-ui
✔ Peper en zout
✔ Olie


Bereiding voor vier personen
• Kook de pasta volgens de aanwijzingen op de verpakking. Giet af en bewaar een kopje kookvocht.
• Snijd ongeveer 2 cm van de onderkant van de asperges af en gooi deze weg (deze is hard). Was de asperges en snijd ze schuin in stukken van ca. 3 cm. Verwarm een wok met een scheutje olie en bak de asperges 3 minuten.
• Snijd de rode ui in halve ringen en voeg toe. Schenk de kookroom erbij, pluis de gerookte zalm uit en voeg toe aan de pan. Laat het geheel 2 minuten zachtjes pruttelen. Voeg de pasta toe en breng op smaak met peper en zout.
• Meng alles goed en garneer met fijngesneden lente-ui.



✔ 2 avocado’s
✔ 2 eieren
✔ 1 rode ui
✔ 2 el mayonaise
✔ 50 g rucola
✔ 4 plakken
Serranoham


Bereiding voor vier personen
• Kook de eieren hard en laat ze schrikken. Pel ze, snijd in blokjes en doe in een ruime kom. Halveer de avocado’s, verwijder schil en pit, snijd in blokjes en voeg toe aan de eieren.
• Snipper de rode ui zo fijn mogelijk en meng met de mayonaise, peper en zout naar smaak. Roer goed door tot een romige salade.
• Snijd de baguette open en beleg royaal met de avocado-eiersalade. Verdeel er wat rucola over voor een knapperige accent.
er voor een knapperige accent.
• Leg de Serranoham erop en snijd de baguette in vier gelijke stukken.

Geen Serranoham in huis? Parmaham of een goede droge ham werkt ook prima. Net iets minder Spaans, maar nog steeds lekker. Serranoham wordt luchtgedroogd in de berggebieden van Spanje, terwijl Parmaham uit Italië met zeezout wordt ingewreven en langer rijpt.
m uit
g de erop en ijd baguette in lijke stukken.
















Ingrediënten (voor 2 personen): (voor 2 personen):
300 gr kikkererwten
150 gr couscous
10 cherrytomaatjes

Bakje Maza falafel
Bakje Maza Hoemoes
12 kalamata olijven
2 el ingelegde uien
Handvol rucola
Olijfolie, peper, zout
Scan mij Scan voor meer meer recepen


B ereiding: Bereiding:
1. Verwarm de oven voor op 200 graden.
2. Bekleed een bakplaat met bakpapier en verdeel de kikkererwten hierover. Besprenkel ze met wat olie, peper en zout en rooster ze daarna 20 minuten in de oven.

3. Kook ondertussen de couscous zoals aangegeven op de verpakking. Halveer de cherrytomaatjes.
4. Bak de falafel volgens de aanwijzingen op de verpakking.
5. Neem twee kommen en vul ze met de couscous, kikkererwten, tomaatjes, falafel, een schep Hoemoes, de olijven, ingelegde uien en top af met olijfolie, peper en zout.




We gaan weer het seizoen in van lekker zomers eten: barbecue, frisse salades, gezonde sandwiches en allerlei tapashapjes. En dat alles natuurlijk in combinatie met heerlijke, frisse witte wijnen of rosé. De populairste witte wijnen van dit moment zijn Riesling, Pinot Blanc, Pinot Grigio en natuurlijk de Verdejo, die tegenwoordig op bijna elke wijnkaart te vinden is. Voor rosé, dé zomerse wijn bij uitstek, staat de blush Pinot Grigio Rosé nog altijd op eenzame hoogte. Maar ook de Rosé d’Anjou, een klassieker uit de Loire met veel rood fruit en een subtiel zoetje, is weer volop in trek. Hou je toch meer van rood? Kies dan voor een Pinot Noir, licht gekoeld tot zo’n 12 graden. Heerlijk bij bijvoorbeeld gegrilde zalm. Wat je smaak ook is: er is altijd een passende wijn voor jou bij Dirck3.



Een aangenaam frisse witte wijn met aroma’s van rijpe peer, groene appel en een subtiel kruidig randje. Licht en soepel in de mond. Ideaal voor wie van droge witte wijn houdt met een vriendelijke afdronk.
LEKKER BIJ: een zomerse pastasalade of als borrelwijn.
Deze frisse, fruitige rosé is gemaakt van een elegante blend van Carignan, Cinsault en Grenache. Je proeft tonen van framboos en perzik. Geen wonder dat deze wijn meer dan vierduizend recensies kreeg op Vivino.

Een tikje zoet, een beetje zuur en vooral heel lekker: de Disaronno Sour is je nieuwe favoriete weekendcocktail.
Vul een shaker met ijs.

3
Optioneel: voeg een scheutje eiwit toe voor schuim. 4 Shake stevig.

2
Voeg 45 ml Disaronno amaretto, 30 ml citroensap en 15 ml suikersiroop toe.













5 Schenk uit in een glas met ijs.


6 Garneer met een citroenschijfje of kers.
LEKKER BIJ: alles van de BBQ, (vis-) salades of als aperitief.










Verdejo is dé allemansvriend onder de witte wijnen: droog, fris en met nét dat beetje pit. Geen wonder dat deze Spaanse favoriet zo goed samengaat met tapas. Denk aan sappige cherrytomaatjes, olijven, gegrilde paprika, serranoham en manchego – die romige schapenkaas die het altijd goed doet bij een glas wijn.












Met haar werkdag net achter de rug en een training op de planning, pikt
Lot Dijkman onderweg een lichte maaltijd mee bij haar favoriete Dirk van den Broek. Een handig ritueel op drukke dagen.
„Ik wil niet te zwaar eten voordat ik ga sporten”, zegt Lot Dijkman (34) terwijl ze een pak quinoa in haar kar legt. „Met wat verse groenten, kip en halloumi heb ik een voedzame maaltijd die me energie geeft, maar waar ik niet te vol van raak op het veld.” De keuze voor Dirk is bewust. „De verse groenten zijn hier altijd goed, en de prijzen van halloumi en kip vallen me telkens weer mee.” Terwijl ze door de winkel loopt, valt haar oog op een aanbieding: een pot honing. Ze glimlacht. „Die kan ik niet laten staan. Handig voor in mijn yoghurt of thee.”
Lot winkelt niet alleen bij Dirk vanwege de scherpe prijzen en de kwaliteit van de
producten. „Het is overzichtelijk”, zegt ze. „Even snel boodschappen doen gaat hier gewoon gemakkelijker.” Ook de aanbiedingen spelen een rol. Vooral omdat je volgens de Dirk Prijs Principes geen grote hoeveelheiden hoeft te kopen om korting te krijgen. „Er zijn altijd fijne acties op producten die ik toch al vaak gebruik en dat scheelt gewoon in de portemonnee.” Wat voor haar minstens zo belangrijk is de sfeer. „Het personeel is vriendelijk en het voelt hier gemoedelijk.”
Gezond én betaalbaar
Daarnaast waardeert Lot dat ze bij Dirk ruime keuze heeft in gezonde en verantwoorde producten. „Je merkt dat ze hier steeds meer biologische en duurzame opties aanbieden, zonder dat je daar de hoofdprijs voor betaalt”, zegt ze. „Ik let graag op wat ik eet, maar het hoeft geen fortuin te kosten.” Met een goedgevulde tas vertrekt Lot richting de hockeyclub. „Ik ben weer goed voorzien”, zegt ze met een tevreden lach. ■
















Sinds het huwelijk van Willem-Alexander met Máxima zijn wij als Nederland verbonden met Argentinië. Maar wat weten we eigenlijk van het Zuid-Amerikaanse land waar onze koningin vandaan komt?
Heeft Argentinië meer te bieden dan vermaarde voetballers, de sensuele dansbewegingen van de tango en de musical over Evita Perón, met het beroemde nummer ‘Don’tCryformeArgentina’?

ARGENTINIË
Argentinië heeft een enorme natuurpracht. Denk aan de ruige bergketens van de Andes, de imposante gletsjers van Patagonië, de uitgestrekte pampa’s met zijn gaucho’s en runderen, de watervallen van Iguazú en de wijnlandschappen van Cafayate en Mendoza. Maar ook is er de bruisende stad Buenos Aires.
Het onmetelijk grote land (meer dan tachtig keer groter dan Nederland) heeft enorm veel te bieden. DenD reisde af naar het noordwesten van Argentinië, maar eerst verkenden we Buenos Aires, op de fiets!
Dwaze Moeders
Het is al tropisch warm als we ons ’s ochtends melden voor de fiets-









tocht bij het monument van de gevallenen in de Falkland-oorlog van 1982 - dat conflict houdt de gemoederen in Argentinië nog steeds bezig. Vervolgens fietsen we langs de Palacio Barolo, de eerste wolkenkrabber van Zuid-Amerika. We passeren de oude, gerestaureerde haven met moderne architectuur van Puerto Madero, met zijn prachtige Puente de la Mujer-brug. Ook fietsen we langs de vermaarde volkswijk La Boca met haar ‘tango-toeristenval’ en het imposante stadion van Boca Juniors. We passeren de wijk San Telmo met haar zondagsmarkt om te eindigen op het Plaza de Mayo, het immense plein dat bekend is van de Dwaze Moeders. Helaas was er geen tijd meer om de duurdere wijk Recoleta met haar restaurantjes, barretjes en terrasjes te bezoeken, de wijk waar Máxima haar jeugd heeft doorgebracht.






Oneindig wit zout k w e e ca va v on za Pa op Salinas Grandes.


De schoonheid van het landschap is ongeëvenaard
In het Noordwesten van Argentinië ligt de plaats Salta, de uitvalsbasis voor een bezoek aan de authentieke indianendorpen Purmamarca en Tilcara en de zoutvlaktes van de Salinas Grandes, dat op een hoogte van 3.450 meter ligt. De ritten naar deze plaatsen zijn adembenemend: tientallen haarspelbochten, indrukwekkende vergezichten, immense rode berg-




Parque Los Cardones.
ketens, zinderende woestijnen, uitgeslepen en droge rivierbeddingen en onnoemlijk veel cactussen. De schoonheid van het landschap is ongeëvenaard. En dat zal gedurende de bijna 1.400 kilometer lange reis naar Mendoza zo blijven. We vallen van de ene verbazing in de andere. De Ruta 40 is met een lengte van ruim vijfduizend kilometer één van de langste wegen ter wereld en loopt vanaf de grens met Bolivia helemaal tot het uiterste zuiden van Argentinië. Delen van Ruta 40 zijn onverhard, maar dat maakt de reis
Lama’s in de Andes, een vertrouwd beeld in het ruige berglandschap.


































er alleen maar avontuurlijker op. Het aantal nederzettingen dat we tegenkomen is op de vingers van één hand te tellen. Tegenliggers zijn er nauwelijks, alleen moeten we waakzaam zijn voor overstekende lama’s, wilde paarden en ezels.
Wild West
In Cafayate drinken we in één van de vele bodega’s ons eerste wijntje van de Torrontes wijngaarden en wagen we ons wederom aan de parrilla, waarbij vlees boven een open vuur wordt gegrild. Eigenlijk gewoon een barbecue, met dat verschil dat de hoeveelheid vlees van de bife de lomo of de bife de chorizo zo enorm groot is dat het eigenlijk afbreuk doet aan de fantastische smaak ervan. Op weg naar San Agustin del Valle Fertil bezoeken we het Nationale Park Talampaya, waar we uitsluitend met een 4-wheel drive-bus door de prachtige canyons en ‘kunstig’ geërodeerde rode rotsen toeren. Het lijkt wel Wild West; het ontbreekt alleen nog aan cowboys en hun paarden.
Dinosaurussen









Het Nationale Park Ischigualasto dat midden in een woestijnlandschap ligt, is nabij. Het park is bekend


omdat er dinosaurusfossielen zijn gevonden. Het kan bezocht worden met de eigen auto. Minstens zo interessant is het museum met zijn opgezette dinosaurussen en prehistorische beesten die hier ooit hebben rondgelopen.

usnden. orden
Onderweg naar Mendoza doen we een pelgrimsoord aan waar het mirakel Difunta Correa wordt aanbeden. De vrouw Deolinda liet daar het leven op zoek naar haar echtgenoot die vocht in de Argentijnse burgeroorlog. Haar kind overleefde haar dood door te drinken van de moedermelk. Daarna zijn er allerlei mirakels gebeurd en is Deolinda een mythisch figuur geworden in de volksreligie. Om
ha te w s al on esc van Messi w
haar gunstig te stemmen, worden nog steeds de meest alledaagse en onooglijke dingen geschonken. Maar ook het voetbalshirt waarmee hij kampioen is geworden, hangt in een van de vele vitrines.
In Mendoza beëindigen we onze reis. We verblijven er op een Finca Garciarena, een wijnboerderij tussen de wijnranken met uitzicht op de besneeuwde bergtoppen van de Andes. Van daaruit bezoeken we ook enkele andere wijnboeren, onder wie Susanna Balbo – een Argentijnse wijnmaakster – en de wijnhuizen Salentein (opgericht door wijlen Mijndert Pon) en Terrazas de los Andes. We doen ons te goed aan heerlijke lunches met de bijpassende Malbec en Merlot. Argentinië heeft ons verrast. Máxima heeft het voor ons lang geheim kunnen houden. Het was alleen spijtig dat bijna geen enkele Argentijn die wij hebben ontmoet, ooit van onze koningin Máxima had gehoord. ■



















ONS DROOMHUIS STAAT IN…
Palmbomen, een zwemvijver en totale rust. Bij CoCo Cabin beleef je een tropische vakantie, gewoon in Nederland. Linda en Jan Jorren creëerden deze idyllische plek midden in het groen.
Linda en Jan Jorren Roepert wonen met hun drie kinderen tussen de weilanden en bossen van Woudenberg. Jan Jorren ontwerpt tuinen, Linda werkte achttien jaar als fashion designer. Tijd voor iets nieuws, vonden ze. Hun liefde voor natuur en design kwam samen in hun eigen droomplek: CoCo Cabin. „Dit is geen doorsnee verblijf”, vertellen Linda en Jan. „Met een zwemvijver, een waterval, een strand en palmbomen voelt het alsof je op een tropisch eiland bent. En dat gewoon in Nederland, in onze achtertuin!”
Huurder Manon:
„Wat een fantastische plek! Het huisje is met zoveel aandacht ingericht. Veel privacy. Heel erg schoon. Goede communicatie met de verhuurder.”
komen genieten. Onze gasten uit binnenen buitenland variëren van wandelaars en yogaliefhebbers tot jong publiek dat de tropische sfeer waardeert.” CoCo Cabin ligt verscholen in een grote privé tuin, met weids uitzicht over weilanden en bossen. „Het is echt een plek voor ontspanning en reflectie. Vanaf de veranda aan het water kun je heerlijk loungen en uitkijken over de zwemvijver, met op de achtergrond het rustgevende geluid van de waterval. Voor wie durft, is er zelfs een koud dompelbad.”

NEDERLAND
Sinds mei vorig jaar verhuren Linda en Jan deze bijzondere plek. „We worden erg blij van alle enthousiaste gasten die hier
Op het strand kun je barbecueën en ‘s avonds een kampvuur maken. „Het tiny house is bescheiden van formaat, maar biedt alle luxe en comfort. Je kunt er koken, ontspannen douchen in de stijlvolle badkamer en heerlijk slapen op de slaapvliering.” Hier kom je tot rust. „Verken het buitengebied van Woudenberg, Scherpenzeel en Leusden, met prachtige natuurgebieden, of breng een bezoek aan levendig Amersfoort.” ■

Woudenberg

GESCHIKT VOOR 1-2 personen
BOEKEN
Geen boekingskosten en direct contact met Linda & Jan Jorren.
BEOORDELING 9,8
MEER INFO? Scan de QR-code

OOK JOUW VAKANTIEHUIS VERHUREN? Begin met verhuren en ontwerp vrijblijvend je advertentie op Micazu.nl


Van een meeslepende opera tot een oogstrelende tentoonstelling. Deze lentemaand valt er weer van alles te ontdekken en beleven!

Jumping Jack is dé urban trampolinehal in Almere. Waan je in metropool New York, word professioneel freerunner op de airfloor en leer freestylen op 2400 vierkante meters aan trampolines. jumpingjack.nl
In de familievoorstelling Zing mee met Annie M.G. wordt het werk van Nederlands bekendste schrijfster Annie M.G. Schmidt gevierd. De mooiste kinderliedjes in een licht klassiek jasje! Van 1 mei tot en met 8 juni. zingmeemetanniemg.nl


Waar willen we naartoe?
Kunstmuseum Den Haag biedt ruimte aan nieuwe vergezichten. In New New Babylon: Visions for Another Tomorrow delen toonaangevende en opkomende beeldend kunstenaars en activisten hun perspectieven vanuit de hele wereld. Waar komen we vandaan, waar zijn we en waar willen we naartoe? Tot en met 31 augustus te zien.
In de impressionismetentoonstelling Nieuw Parijs staat de verbeelding van Parijs centraal. Over een keerpunt in de kunstgeschiedenis met o.a. Monet en Morisot. Tot en met 9 juni te zien in Kunstmuseum Den Haag. kunstmuseum.nl


Kunst als ideologisch fileermes. De tentoonstelling EVERYTHING IS TRUE - NOTHING IS PERMITTED toont hoogst explosief werk van onder anderen Marina Abramovic, Cassils en Regina José Galindo. Tot en met 15 juni in Brutus in Rotterdam. brutus.nl















Van oer-Hollandse vlaflip tot een koninklijk dessertbuffet. In kunstmuseum Den Haag staat de geschiedenis én het plezier van het toetje in Europa centraal. De tentoonstelling Grand Dessert is verlengd tot eind oktober. kunstmuseum.nl













ende, gratis ositie
De zinnenprikkelende, gratis toegankelijke expositie

An exercise in Joy van Bas Kosters is van 17 mei tot en met 6 juli te zien in Artzaanstad. Met kleurrijke en vreugdevolle wandkleden, schilderijen, keramiek en nog veel meer. artzaanstad.nl

an 17 mei e zien in gde, miek













1
Gratis festival op 5 mei met grote artiesten om de vrijheid uitbundig te vieren.
2
Culinair festival vol foodtrucks en livemuziek in het gezellige Westerpark. Van 28 mei tot en met 1 juni.
3
Gezellig bluesfestival met internationale artiesten en heerlijke spareribs voor jong en oud. Op 7, 8 en 9 juni.
4
BEST KEPT HILVARENBEEKSECRET,
Intiem muziekfestival met topacts en een sfeervolle setting tussen bossen en water. Op 13, 14 en 15 juni.
Een gevarieerd programma voor jong en oud op de Dorpsweide van Wijk aan Zee. Van 28 mei tot 1 juni.



In ons LAM museum willen we je het bijzondere laten ontdekken in het gewone. Er zit schoonheid in de dingen die je gedachteloos in boodschappenmandje gooit, in de pan bakt en in je mond stopt. Er zit zelfs schoonheid in de koffievlek op je bureau of een verfomfaaid bonnetje dat je opdiept uit je jaszak. Het is maar hoe je ernaar kijkt. En dát je ernaar kijkt.
Kunstenaar Daan van Golden (1936 – 2017) wist dat als geen ander. Hij gaf alledaagse dingen een podium. Bijvoorbeeld door een gevonden stukje inpakpapier of theedoek te bestuderen en het perfect na te schilderen. Hij fotografeerde ook, voornamelijk zijn opgroeiende dochter Diana, want ‘jeugd is een kunst’.
Wie zich wil onderdompelen in de schoonheid van het gewone leven, kan tot en met 14 september 2025 naar de tentoonstelling ‘Daan van Golden. The Original’ in Stedelijk Museum Schiedam.

Daan van Golden groeide op in het rauwe, Rotterdamse Katendrecht. Als jongetje had hij een fascinatie voor bomen. Hij wilde tuinman worden. Zijn stiefvader vond het maar niets en stuurde hem naar de ambachtsschool. Later volgde Van Golden de avondacademie voor Beelden Kunsten en werkte hij als etaleur voor de Bijenkorf.
Iedereen wil origineel zijn, toch? Daan van Golden keek er anders naar. Alles is er al, vond hij. Hij wilde niets nieuws creëren, maar de schoonheid zien van wat er al was. En daarin was hij behoorlijk origineel.
Sietske van Zanten is directeur van het LAM, gewoon een bijzonder museum. In het LAM, midden in het groen van Landgoed Keukenhof in Lisse, ga je bijzonder kijken naar heel gewone dingen. Volg het museum op Instagram via @lam_museum of bezoek lammuseum.nl.


m nl. h z Zo tijd een J


Het kunstenaarschap was niet de enige bron van inkomsten. Als er geld nodig was, nam hij baantjes aan die op zijn pad kwamen. Zo figureerde hij tijdens een reis in een Japanse film.



Toen Daan van Golden als kunstenaar begon, werd hij Daan Black Hands van Golden genoemd. Hij schilderde vooral met zwarte verf. In 1963 reist hij voor langere tijd naar Japan. Daar verandert alles. De Japanse verfijndheid raakt hem. Als hij een stukje inpakpapier op de grond ziet liggen, besluit hij dat heel precies na te schilderen. Het is het einde van zijn woeste stijl en het begin van de kunst waarmee hij beroemd zal worden.
DAAN VAN GOLDEN SCHILDERDE
ZAKDOEKEN, THEEDOEKEN, INPAKPAPIER EN ANDERE ALLEDAAGSE PATRONEN NA. DOOR JAPANSE LAKVERF TE GEBRUIKEN, ZIE JE BIJNA NIET DAT HET GESCHILDERD IS, ZO STRAK OOGT HET!

RIJKE VROUWEN DROOGDEN VROEGER ZELF HUN KOSTBARE EN KWETSBARE THEEKOPJES AF. DE HANDEN VAN DE DIENSTMEISJES ZOUDEN TE GROF ZIJN. VAN DE DOEKEN DIE ZE DAARVOOR GEBRUIKTEN, KOMT DE NAAM THEEDOEK.
Het gewone leven is minstens zo interessant als de kunst, vond Daan van Golden. Geen wonder dat hij juist toevallige momenten en alledaagse voorwerpen als zijn onderwerp nam voor zijn kunstwerken.

Daan van Golden woonde en werkte het grootste deel van zijn leven in Schiedam. In het altijd fijne Stedelijk Museum Schiedam zijn tot en met 14 september 2025 tachtig topstukken van hem te zien. stedelijkmuseumschiedam.nl











Jisse Kuipers (14) was in 2024 de winnaar van het Koninklijk Concertgebouw Concours. Dit muziekevenement wordt sinds 2009 jaarlijks georganiseerd voor kinderen in de leeftijd van negen tot veertien jaar. De jonge trombonist won eerder al het Prinses Christina Concours en begin dit jaar het gouden FMDT-solistenconcours in Tytsjerksteradiel. DenD stelt 7 vragen aan dit jonge muzikale talent uit Hurdegaryp, Friesland.
1
Jedeeddriekeermee aanhetKoninklijk Concertgebouw Concours.Hoe was dat?
„Het was echt superleuk om mee te mogen doen. Heel bijzonder ook, want het was in het Amsterdamse Concertgebouw. En dat is zó mooi! De eerste keer dat ik meedeed was ik erg nerveus, maar je groeit er daarna een beetje in. Het contact met de andere kandidaten was heel goed. De onderlinge sfeer was gezellig. Ik heb nu niet veel contact meer met ze, maar soms kom ik iemand tegen, op een concert bijvoorbeeld. Dat is altijd leuk.”
2
Hoeveelprijzenheb jeenopwelkebenje het meest trots?
„Ik heb ze niet nageteld, maar ik denk een stuk of twintig. De twee prijzen waar ik het meest trots op ben, zijn die van het Koninklijk Concertgebouw Concours en het Prinses Christina Concours. Ik hoop in de toekomst ook nog een internationale prijs te winnen.”
3
Jespeeldeopje zevende al trombone. Hebjeooiteenander instrumentwillenbespelen?En hoeveeluuroefenjeperweek?
„In eerste instantie wilde ik bastrombone spelen, maar dat instrument was voor mij nog net te groot. Dus toen ben ik met de tenortrombone begonnen en dat bleek een heel mooi instrument te zijn. Ik speel elke dag. Hoe lang? Dat hangt een beetje af van de tijd die ik op een dag kan vrijmaken. Maar ik speel minstens een uur - en vaak langer.”
4
En dat combineer jemetschool?
„Ja, ik zit op het CSG Liudger in Burgum; ik doe VWO Meertalig. Daarna wil ik heel graag naar het conservatorium. Welk conservatorium dat wordt, weet ik nog niet. Het kan Amsterdam zijn, maar ook een conservatorium in het buitenland. Het hangt ervan af waar ik tegen die tijd de beste docenten kan vinden.”
5
Komjeuiteen muzikale familie?
„Ik heb de muzikaliteit zeker van thuis meegekregen. Mijn vader speelde bastuba en mijn moeder de althoorn. Mijn zus Roas is onlangs gestopt met trompetspelen. Jammer, want ze is echt heel erg goed.
6
Naar wat voor muziekluisterje zelf graagenhebje nogtijdvooranderehobby’s?
„Ik luister een beetje naar alles. Naar klassieke muziek, maar ook gewoon naar popmuziek en natuurlijk brassbandmuziek. Maar voor wat betreft het zelf spelen, is het vooral klassiek en brassband. En wat betreft andere hobby’s? Ik ga een paar keer per week naar de sportschool voor krachttraining en ik vind het leuk om te wandelen met onze hond Ribe.”
7
Wiezijnjegrootste fans?Jeouders of klasgenoten?
„Mijn hond Ribe is mijn allergrootste fan! Elke keer als ik begin te spelen, begint hij meteen mee te janken. Hahaha. Maar natuurlijk zijn mijn ouders ook erg trots.
Mijn klasgenoten vinden het volgens mij allemaal wel grappig, maar hun interesse ligt toch ergens anders, denk ik.” ■


Het Koninklijk Concertgebouw Concours zet ook dit jaar nieuwe talenten in de schijnwerpers. 24 mei is de halve finale; 8 juni de Masterclass voor de finalisten en op 28 juni is de finale. Het Concours, dat dit jaar voor de 17e keer plaatsheeft, wordt mede mogelijk gemaakt door de VandenBroek Foundation. Deze stichting wil jong, cultureel talent stimuleren en het plezier van kunst doorgeven aan een breed publiek.































































ScAn eN pRoEf dE sFeEr ScAn eN dE oP hEt JaN fEsTiVaL oP hEt JaN fEsTiVaL.

ReCePtEn ReCePtEn sPeLlEtJeS & mEeR & mEeR































Vroeger deelde

aan de keukentafel. Nu
Vroeger deelde je je scheiding fluisterend mee aan de keukentafel. Nu snij je een taart aan, omringd door vriendinnen, met een glas bubbels en Beyoncé op de achtergrond.

Scheidingsfeestjes zijn in, en ja: er is ook taart met
glas bubbels en op de zijn in, en er is ook taart met z’n hoofd erop.

In Amerika weten ze al jaren: als de liefde over is, vier je dat met een knal. Denk Las Vegas, dé divorce party-hoofdstad, waar vrouwen hun vrijheid toosten met een taart mét een doodgeslagen bruidegom erop. En ja, ook ons land gaat eraan geloven. Het begon in 2006, toen ene Christine Gallagher – zelfgekroonde koningin van de scheidingsfeesten – haar vriendinnen uit het relatiepuin trok met slingers en een Beyoncé-playlist. Haar



Divorce Party Handbook werd een hit: tips om je ring ceremonieel te begraven onder confetti of je trouwjurk ritueel in de fik te steken. Las Vegas werd dé plek van de breuken: voor een paar duizend euro regelde je daar een scheidingsfuif een diner, toespraken over je gestrande huwelijk en piñata’s om je exgeliefde symbolisch af te rossen.





van Travis Barker) beet het spits af: ze serveerde een taart met een suikeren versie van haar ex erop, die tijdens het dessert genadeloos werd onthoofd. Haar vriendinnen





Shanna Moakler (ex
tti of k te steken. van de liefdesduizend euro eidingsfuif met over su thoofd. kirden, de prosecco vloeide.

T WIJFELAAR S
TWIJFELAARS


doorgaans nuchter,
In Nederland zijn we maar inmiddels waait ook hier de

Verbrand de band met je ex-geliefde.








scheidingsglitter over. Op het spraakmakende scheidingsevent Let’s Divorce!(14 juni, Brabanthallen, Den Bosch) staan tattoo-artiesten klaar om 'Kevin 4ever' in te ruilen voor een roos, slang of phoenix. Laat je frustratie los in de Smash Your Ex Room, snij een symbolische punt uit de Divorce Cake, of boek een singles-
trip naar Bali. Ook kun je terecht voor speeddates en en workshops van mediators, coaches en advocaten. Initiatiefnemer Simone Vermeer legt uit: „Ik weet uit eigen ervaring hoe slopend een (vecht)scheiding kan zijn. Juist daarom wil ik anderen helpen de angst voor het onbekende te overwinnen en inzicht te krijgen in de opties.”
GEEN PRETJE
Scheiden is allesbehalve een pretje. In 2023 spatten 23.817 huwelijken in Nederland uiteen, en 2024 belooft – volgens het CBS – nóg grimmiger te worden. Tel daar nog 2.092 gesneuvelde partnerschappen bij op, en je snapt: één op de drie stellen kiepert vroeg of laat de ring de sloot in. Maar het echte drama komt van de huizenmarkt: 52,4 procent van de toekomstige exen slaapt er slecht van. Met huizen die gemiddeld €419.000 kosten en een tekort van 390.000 woningen is een nieuw stekje vinden een hel. En heb je kinderen, dan wil je niet naar Timboektoe verkassen.
CHAOS
Met al dat drama rondom scheidingen klinkt een feestje ineens een stuk aantrekkelijker. Geen vechtscènes, wel een toost op de toekomst. Want het draait niet (alleen) om wraak, het gaat om loslaten met
stijl. In de VS snappen ze dat allang: daar regel je een scheidingsplanner, stel je een verlanglijstje samen (hallo Airfryer, nieuwe lakens, gastendoekjes) en boek je een luxe pakket om je relatie officieel ten grave te dragen. Maar het is niet alleen glitter en ironie. Zo’n feest kan oprecht iets betekenen. Sommige stellen geven zelfs sámen een scheidingsfeest, om aan kinderen en familie te laten zien: het kan wél, uit elkaar gaan zonder oorlog.
Ook in Nederland kun je je scheiding tegenwoordig met confetti afsluiten. Denk: Divorce Hotel, waar je in een weekend én uit elkaar gaat én
een borrel krijgt. Weddingplanner Nederland regelt intieme borrels of strandfeestjes, FeestIdee knalt met vol slingers, draaitafels en een taart met een gebroken hart. Of troostfeestjes en evenementen als Let’s Divorce! je écht door de ellende slepen (of gewoon zoete afleiding zijn, moet iedereen zelf uitvogelen. Misschien snijdt die Divorce Cake wel dieper dan alleen door marsepein. Simone zegt het zo: „Scheiden betekent niet per se een ellendig einde; het is een reset.” Wij voegen daaraan toe: wie een groots begin had, verdient net zo goed een groots afscheid. ■



Vechtscheiding lijkt de norm. Kijk naar de ravage van Sieneke en Jan Baum Frank Jansen en Rogier Smit, Lil’ Kleine en Jaimie Vaes, het ex-circus van Sylvie en Rafael, of Gers Pardoel en zijn geruchtmakende breuk. Zelfs Wesley Sneijder en Yolanthe Cabau hielden het niet netjes. In Hollywood is het al helemaal één grote emotionele slachtbank, met Angelina Jolie en Brad Pitt of Jennifer Lopez en Ben Affleck Maar het kan ook anders… met een scheidingsfeest! met een












































PROBEER HET ZELF!



















































































































































































Wie
Aimee Lou Wood zeker al gespot als Chelsea, één van de gasten in het Thaise resort. zeldzamer is dan rimpels: een stel tanden dat gewoon zichzelf mag zijn.

e seizoen 3 kijkt, heeft s mee Lou Wood zeker al als elsea, één van de in het Thaise e sort. Ze heeft iets wat in Hollywood dzamer is dan een stel nden dat zichzelf mag zijn. . Vroeger noemde ze dat op het schoolplein ‘ konijnentanden’, nu is het haar handelsmerk. Of eigenlijk: haar goudmijn.




2016-2017: Debuut in het theater met Mary Stuart en People,Places &Things.
2019: Doorbraak als Aimee Gibbs in Sex Education(Netflix).
2021: Speelt in The Electrical Life of Louis Wain. Wint een jaar later de BAFTA TV Award voor Beste Vrouwelijke Komische

Prestatie voor haar rol als Aimee Gibbs in Sex Education.
2022: Hoofdrol in Living.
2023: Debuut op West End in Cabaret
2024: Hoofdrol en producer van BBCserie Daddy Issues.
2025: The White Lotus(HBO) seizoen 3.






NAAM: Aimee Lou Wood.
GEBOREN: 3 februari 1994 in Stockport, Greater Manchester.
OPLEIDING: Royal Academy of Dramatic Art.
RELATIESTATUS: Single sinds de breuk met Sex Education tegenspeler Connor Swindells.




Op Netflix strijdt ze in Toxic Town als rouwende moeder tegen een giftig-afvalschandaal. In Sweet Dreams belandt ze in een nachtmerrie vol fraude, moord en mislukte dromen. En dan is er Film Club(BBC). Daarin speelt ze Evie, een vrouw die zich liever verliest in haar filmclub dan in het echte leven.

De cast van The White Lotus woonde tijdens de opnames op de set, compleet met persoonlijke butlers en een open bar. Maar luxe heeft een prijs: prosecco tikte $150 aan en de airco moest uit vanwege het geluid. Ontsnappen kon alleen tussen het filmen door: zwemmen, boksen of een spirituele zoektocht in een veel te dure spa. Sommigen bereikten verlichting, anderen een six-pack. Hollywood blijft Hollywood.






Oh constant rondlop ro came
„Het eerste wat ik dacht toen ik de rol kreeg, was: Oh god, ik moet constant in bikini rondlopen op camera”



„Ik wo klein Zu Londe zó Br man
„Ik woon in mijn kleine flatje in ZuidoostLonden en ben zó Brits in mijn manier van doen”
„Alles wat ik doe, lijkt reacties op te roepen. Mensen hebben het erover dat ik geen facings of Botox heb, en dat voelt een beetje rebels” en en its in mijn nier van oen”






„Onbeleefdheid, geen dankjewel zeggen en onvriendelijk zijn, dat zijn enorme afknappers voor mij”




Georgia May Jagger.
Dat haar tanden hét gespreksonderwerp zijn, zegt alles. In Hollywood heeft zij iets revolutionairs: bunnyteeth, bovenste snijtanden die nét uitsteken en in LA doorgaans met een beugel worden uitgeroeid. Vroeger schaamde de Britse actrice zich, tot ze inspiratie vond bij Georgia May Jagger, dochter van Mick Jagger. ,,Ik had nog nooit een actrice op tv gezien met tanden zoals die van mij. Toen Georgia Jagger de ‘Get the London Look’reclame deed en met haar spleettanden verscheen, was dat een groot moment. Dus dacht ik: Ikgarodelippenstift dragenendeaandachterop vestigen.”







































































Nikkie Plessen is jarig. Veertig kaarsjes op de taart, een mode-imperium en een huis aan het Vondelpark waar de champagnefontein waarschijnlijk standaard aanstaat. Maar één ding ontbreekt nog: een trouwring.


Niet dat Nikkie Plessen het niet geprobeerd heef, om de bruid te worden. Ruben Bontekoe, haar grote liefde, kreeg van haar een simpele opdracht mee: Je hebt tot mijn veertigste om een aanzoek te doen, daarna hoeft het niet meer. En hier zijn we dan. Mei 2024. Veertig lentes jong. En? Nog steeds geen ring aan die perfect gemanicuurde hand. Is de passie in huize Plessen nog haute couture, of liggen de vonken inmiddels in de uitverkoopbak? In @C vertelde Nikkie dat ze het nog best gezellig hebben samen. „Maar het is nou niet zo dat ik me elke dag in een catsuit hijs, huppend door de kamer ren, een radslag naar het bed maak en denk: huppetee! Nee. Maar dat lijkt me herkenbaar voor iedereen met een lange relatie.”
Op haar pootjes...

Twintig jaar samenzijn zonder huwelijksdruk kan op zich prima, maar als je je partner een decennium de tijd geeft om op één knie te gaan en hij schuift het nóg steeds voor zich uit, dan gaat het niet meer gebeuren. Maar catsuit of niet, Nikkie Plessen komt toch altijd op haar pootjes terecht.

ltijd op haar pootjes terrecht. ■














































door Savanna Bosch
TWEELINGEN 22 mei - 21 juni
Je voelt je inspirerend en sociaal. In de liefde ben je speels en avontuurlijk, wat leidt tot nieuwe verbindingen. Op werkgebied krijg je de kans om je creativiteit volledig te benutten. Let op dat je je niet overbelast, want je hebt de neiging om veel tegelijk te doen. Plan momenten van rust in de natuur om je gedachten te ordenen en je energie op peil te houden.
KREEFT 22 juni - 22 juli
Deze periode brengt emotionele rust en versterkte relaties. Je hebt behoefte aan diepe verbindingen met dierbaren, wat je veel voldoening geeft. Professioneel kom je vooruit, maar blijf flexibel. Gezondheid en financiën stabiliseren zich, maar wees voorzichtig met impulsieve aankopen. Breng tijd door in de natuur, wat je helpt om helder te denken en in balans te blijven. Volg je intuïtie voor de juiste keuzes.
LEEUW 23 juli - 22 augustus
Je straalt vertrouwen en energie uit, wat deuren opent in zowel je carrière als relaties. In de liefde is het een tijd van plezier en speelsheid; je hebt de neiging om diepgang te zoeken, wat je verbindt met anderen. Professioneel krijg je de kans om je talenten te laten zien. Gebruik je fysieke energie om nieuwe uitdagingen aan te gaan. Geniet van de zon en de frisse lucht!
MAAGD 23 augustus - 23 september
Je voelt je kalm en gefocust, wat je helpt om zowel werk als persoonlijke projecten goed aan te pakken. In de liefde is het een rustige tijd, beste Maagd. Maar je relatie krijgt wel meer diepgang. Je gezondheid vraagt om aandacht; een nieuwe sport of gezonde gewoonten kunnen je meer energie geven. Breng tijd door in de natuur om op te laden en helder te blijven. Structuur is jouw sleutel tot succes!
WEEGSCHAAL 24 september - 23 oktober
Je charme en rust trekken anderen aan, wat je relaties verdiept. Je hebt behoefte aan harmonie, en dat merk je in alles wat je doet. Op werkgebied ontstaan nieuwe kansen—sta open voor verandering. In de liefde is er ruimte voor avontuur, wat je geest verfrist. Geniet van spontane uitstapjes in de natuur, ze brengen je de ontspanning die je zo hard nodig hebt, Weegschaal. Blijf in het moment!
SCHORPIOEN 24 oktober - 22 november
Je ervaart innerlijke groei en diepere verbindingen met anderen. In de liefde is het een tijd van verdieping, waarin je je openstelt voor kwetsbaarheid. Professioneel ben je in staat om grote stappen te zetten, maar geduld is nodig. Je voelt je fysiek sterk, maar zoek balans door rust te nemen. Buiten zijn helpt je om helder te blijven. Laat oude patronen los en maak ruimte voor vernieuwing!
STIER
21 april - 21 mei
De lente brengt stabiliteit en groei. Zowel persoonlijk als professioneel voel je je zekerder. In de liefde is er ruimte voor verdieping en het versterken van banden. Financieel zie je positieve veranderingen, maar wees voorzichtig met grote uitgaven. Zorg voor jezelf en neem tijd om buiten te zijn; de natuur helpt je te ontstressen en nieuwe energie op te doen. Focus je op langdurige doelen, beste Stier!
BOOGSCHUTTER 23 november - 21 december Je hebt zin om nieuwe dingen te ontdekken, zowel in je persoonlijke leven als op werkgebied. In de liefde ben je speels en avontuurlijk, wat in deze lenteperiode zorgt voor opwindende ontmoetingen. Professioneel krijg je kansen om je horizon te verbreden, maar zorg dat je je niet overbelast. Maak tijd voor spontane uitjes en activiteiten in de buitenlucht. Laat de frisse energie van de lente je inspireren!
STEENBOK 22 december - 20 januari
Je voelt je gefocust en gedreven, wat je helpt om je doelen te bereiken. Zowel op werk als in je persoonlijke leven komt er eindelijk vooruitgang. In de liefde is het een tijd van rust, maar er is ruimte voor verdieping. Gezondheid en financiën vragen aandacht, dus zorg voor een gezonde balans, beste Steenbok. Geniet van tijd in de natuur, het helpt je om je gedachten te ordenen en nieuwe energie op te doen.
WATERMAN 21 januari - 19 februari
Je voelt je inspirerend en vol energie, wat leidt tot nieuwe kansen en ideeën. In de liefde is het een speelse tijd, met veel nieuwe ontmoetingen. Professioneel ben je open voor verandering en innovatie, wat je veel kansen biedt. Maak tijd voor spontane momenten en geniet van de natuur—dit helpt je om je gedachten te verfrissen en de energie te vinden om verder te gaan.
VISSEN 20 februari - 20 maart
Je intuïtie is sterker dan ooit, en dit helpt je om belangrijke keuzes te maken. Zowel op het werk als in de liefde voel je je emotioneel heerlijk in balans. In de liefde is er ruimte voor diepe verbindingen, vooral als je jezelf openstelt. Breng tijd door in de natuur om tot rust te komen en je gedachten helder te krijgen. Deze periode vraagt om innerlijke rust en focus!
RAM 21 maart - 20 april
Je voelt je energiek en klaar voor nieuwe uitdagingen. Zowel in de liefde als op werkgebied komen er verrassingen. Het is een tijd om nieuwe relaties aan te gaan of bestaande te verdiepen. Zorg ervoor dat je niet over je grenzen gaat, maar zoek ook momenten van ontspanning. Buitenactiviteiten brengen rust en helpen je helder te blijven. Geniet van de frisse lente-energie!
















Schaam je er niet voor, stel je vraag aan Lieve. Ze helpt je! lieve@dend.nl.
Hallo Lieve, Mijn vijftienjarige zoon kijkt porno. Moet ik er iets van zeggen of laat ik het gaan? Ik weet het, het hoort erbij. Maar als ik zie wat er online allemaal rondgaat, vraag ik me toch af: denkt hij straks dat échte seks er net zo uitziet zoals in die filmpjes? Ik wil hem niet in verlegenheid brengen of het gesprek ongemakkelijk maken, maar ik vraag me af of en hoe ik hem iets kan meegeven. Wat is wijsheid? XX
Pubers en porno zijn een klassiek duo, net als pubers en een rommelige kamer. Maar als je wilt dat hij begrijpt dat porno geen handleiding is, kun je hem daar best subtiel op wijzen. Geen ongemakkelijke preek, geen ‘laten we samen een documentaire kijken’-moment. Maar een luchtig: ‘Je weet dat échte seks niet zo werkt, hè?’ kan soms al genoeg zijn. En als het goed is, leert je zoon het ook van vrienden, uit series en hopelijk van een beetje fatsoenlijke seksuele voorlichting.
Beste Lieve, Mijn vriendin stuurt dag en nacht appjes naar een collega. Ze lachen om inside jokes, hij weet meer over haar dag dan ik, ze drinken koffie samen, trainen samen. Mijn vriendin zweert dat het platonisch is, maar ik voel me een sukkel. Ben ik paranoïde, of wordt hier emotioneel gesjoemeld?

Rob
Als jij je buitenspel gezet voelt, is dat een knipperend waarschuwingslicht. Nee,
er is geen seks (voor zover je weet), maar emotionele intimiteit met iemand anders kan net zo ontwrichtend zijn als een affaire in bed. Ze deelt dingen met hem die bij jullie relatie horen. De vraag is niet of jij paranoïde bent, maar of zij dit oké zou vinden als de rollen waren omgedraaid. Tijd om de kaarten op tafel te leggen. Voelt ze zich verwaarloosd? Mist ze spanning? Mooi, dan kan ze dat ook samen met jou oplossen… niet op de sportschool. Een relatie is tenslotte geen trio, tenzij dat met wederzijds goedvinden is.
Hi Lieve,
In het begin van onze relatie deed ik alsof ik klaarkwam. Niet uit kwade wil, maar gewoon om de sfeer erin te houden. Nu denkt mijn vriend dat hij altijd raak schiet en verwacht hij hetzelfde enthousiasme. Maar ik wil eerlijk zijn, zonder hem het gevoel te geven dat alles één grote leugen was. Hoe moet ik het aanpakken? Anoniem
Tja, je hebt jezelf aardig klem geacteerd. Stop met faken, punt. Je hoeft hem niet tijdens de daad dramatisch toe te schreeuwen: ALLES WAS NEP! – we willen de sfeer er een beetje in houden. Maar een subtiele koerswijziging is wel op z’n plek. Als hij na tien minuten enthousiast zweten verbaasd
opkijkt en zich afvraagt waar het vuurwerk blijft, is dat je moment. Probeer: ‘Niet alles werkt elke keer hetzelfde’ of ‘Ik wil eens iets nieuws proberen’. Even wennen? Ja. Maar liever nu een klein ongemak dan over twintig jaar nog steeds deze voorstelling opvoeren.





‘Nu denkt mijn vriend dat hij altijd raak schiet’

Er heerst nog altijd het idee dat mannen áltijd zin hebben. Dit stereotype komt deels voort uit verouderde biologische theorieën: mannen zouden van nature jagers zijn, gedreven door testosteron, terwijl vrouwen selectief en afwachtend zijn. Maar is dat wel zo? Onderzoek in het Journal of Sex Research toont aan dat libido schommelt bij zowel mannen als vrouwen, beïnvloed door stress, slaap en relatiekwaliteit. Toch hangt er bij mannen een onuitgesproken verwachting: als je niet wilt, dan klopt er iets niet. Onderzoek van de Universiteit van Chicago laat zien dat dertig procent van de mannen periodes van minder seksuele interesse ervaart, maar daar wordt nauwelijks over gesproken. Dit legt niet alleen druk op hen, maar vertekent ook het beeld van wat een gezond seksleven is. ■



Een goede buur is beter dan een verre vriend!
Heb je een griepje? Wie helpt je dan? Inderdaad de buren! Bij wie kun je je hart uitstorten tijdens een bakkie koffie? Bij je buren! Klein klusje in huis? Je buurman lost het op!
Maak een foto van jou met je favoriete buren en schrijf ons waarom zij voor jou belangrijk zijn. Reageren kan via post@dend.nl









Liesje en haar buren zijn echte vriendinnen.

‘Mijn buuffies zijn goud waard’



ZEGELS VOOR OUDEREN-SOOS
Heb je nog zegels van DE of Trekpleister liggen waar je zelf niets mee doet? Gooi ze niet weg! Onze Ouderen-Soos spaart graag mee en we zouden er ontzettend blij mee zijn.
Leny van Galen
Backershagen 76
3078 SB Rotterdam

E-mail: lenyvangalen@upcmail.nl



Mijn lieve buuffies wonen allemaal in dezelfde straat, we passen op elkaars honden, wisselen tijdschriften uit en helpen elkaar waar nodig. We gaan minstens vier keer per jaar samen op pad, koken voor elkaar of doen een klusje als dat uitkomt. Gewoon buren én vriendinnen. Dit is een foto van ons dagje Scheveningen. Mijn buuffies zijn me goud waard!
Liesje Boer uit Leidschendam



































Dit beeldje van 18 cm kreeg ik ooit van mijn overleden man. Het betekent ontzettend veel voor me. Helaas is het gevallen en zijn de armen van de man afgebroken. Ik hoop van harte dat iemand ditzelfde beeldje nog heeft en het aan mij wil verkopen. Heel graag!
Renea Boomgaard-Profijt

E-mail: reneaprofijt@live.nl






Wie wil ruilen of verkopen? Ik ben op zoek naar miniatuurauto’s uit de jaren 1950 tot 1970 van merken als Matchbox, LEGO, Tekno, Scalextric, Spot-On, Schuco, enzovoorts. Laat vooral van




Ol van den Bosch olvandenbosch@live.nl

v an is . v erdwenen, veran d A fke Reijenga
Ooit was ze Morgen, en kunstenaa wandelen de stekker et spotlig yogahoud Afke een die retr een w ande Af je horen. den Bosc E-mail: olvanden
ik n. el len n rte e fijt e.nl l






Teun van de Keuken en Yvette van Boven bespreken hun lievelingskost. Van een spannend – of juist doodgewoon –ingrediënt tot een praktisch keukenapparaat en van horeca-ervaringen tot kooktips. En wat gaan ze vanavond zelf eten?






Ze waren overal: op tv, in de bladen, op feestjes waar wij nooit binnenkwamen. En toen: stilte. In onze nieuwe rubriek
‘Was dat niet die van…?’ kijken we wat er van ze geworden is. Van soapsterren tot showbizzfenomenen; verdwenen, veranderd of totaal getransformeerd? Eerste in de reeks:

Ooit was ze dé babe van de buis. Baantjer, Onderweg naar , en tussendoor een jetsetbestaan als muze van Micha Klein. Haar cv? Actrice, muze en wandelende afterparty. Rond haar veertigste trok ze de stekker uit het feestgedruis. Ze ging op wereldreis, liet de spotlights achter zich en vond zichzelf terug in een yogahouding onder een palmboom. Tegenwoordig is Afke een yoga-godin en tantratijgerin (@afke_lotus) retreats geeft van Ibiza tot India. Met blote voeten, een wilde bos haar en een brede grijns helpt ze anderen hun ‘heilige sexy kant’ terug te vinden. Afke is nu zen, maar nog steeds een beest!
Verzamelen?
Als u wilt reageren op de verhalen in DenD, of als u iets speciaals zoekt voor uw verzameling, dan kan dat via het volgende e-mailadres: post@dend.nl
Ga voor oplossingen van de puzzels naar: dend.nl/puzzel en voor de prijzen naar: dend.nl/winnen
Ons redactieadres voor brieven en kaarten is: DenD
Donauweg 10 1043 AJ Amsterdam
































Koolhydraat-elektrolytoplossingen verhogen de vochtopname tijdens lichamelijke inspanning. Vitamine B6 draagt bij tot een normale psychologische functie. Het is aanbevolen om een gevarieerd, evenwichtig voedingspatroon en een gezonde levensstijl aan te houden. © 2025 The Coca-Cola Company. POWERADE is a registered trademark of The Coca-Cola Company.











door TAMARA VISSER
Gedragstherapeut voor katten


Hélène met hondje Bobby.
Hélène Hendriks houdt haar privéleven graag buiten de schijnwerpers. Haar partner, Frans Vinju? Geen Instagrammomenten, geen interviews, geen romantische liefdesverklaringen. Maar haar hond Bobbie? Die krijgt moeiteloos alle schermtijd. Zo ook een paar jaar geleden in HLF8, waar Bobbie een wel heel onvergetelijke indruk achterliet. Terwijl Hélène zich met haar gasten bezighield, had Bobbie andere prioriteiten: hij veranderde de studiovloer in zijn persoonlijke toilet. Hélène zelf nam het incidentje luchtig op - hoewel, luchtig...
„Ja, ik moest halsoverkop naar de studio en had geen tijd meer om hem uit te laten”, vertelde ze later bij Vandaag Inside. Dat Bobbie haar grote liefde is, steekt ze niet onder stoelen of banken. „Als ik thuiskom, is het eerst Bobby-tijd”, lacht ze. Frans daarentegen? Die blijft onzichtbaar.
„Mijn familie vindt het niet fijn om op mijn Instagram te staan”, aldus Hélène.

Een kitten in huis? Niemand hoeft moeite te doen om zo’n kleintje aan het spelen te krijgen. Sterker nog, alles is speelgoed! Voor je het weet, sprint hij ervandoor met je schoenveters. Maar waarom verandert dat speelse bolletje energie ineens in een professionele bankhanger?
Naarmate katten ouder worden, lijkt hun speelse gedrag soms te verdwijnen. Sommige baasjes krijgen hun huistijger met geen mogelijkheid meer in beweging, hoe hard ze de speelhengel ook voor zijn neus zwieren. Worden katten echt lui, of is er iets anders aan de hand?
Jachttechnieken
Spel is voor jonge kittens erg belangrijk. Door spel leren zij motorische vaardigheden en oefenen zij jachttechnieken.

Daarnaast is het ook van sociaal belang; zij leren in spel met andere katten allerlei lichaamshoudingen aan te nemen en leren van elkaars reacties.
Naarmate kittens ouder worden, zal het spelgedrag afnemen.
Uitlaatklep
Spel blijft echter belangrijk, ook voor volwassen katten.






Heeft u meerdere katten? Dan is er vast altijd eentje die tijdens een speelsessie het voortouw neemt terwijl de anderen toekijken. Is dat omdat de toeschouwers geen zin hebben? Nee, die zijn simpelweg wat meer bescheiden en geven voorrang aan hun enthousiaste soortgenoot. Plan daarom met iedere kat individuele speelmomenten in, zodat ook wat meer bescheiden types hun kans krijgen om te spelen.


DenD-Dierenwereld werkt samen met

Het is namelijk een uitlaatklep voor hun energie en het zorgt ervoor dat ze zich niet gaan vervelen. Daarnaast worden er tijdens spel stofjes aangemaakt in de hersens waardoor de kat zich prettiger gaat voelen. Spel is dus niet alleen belangrijk voor kittens, maar ook voor volwassen katten, hoewel de mate waarin per kat kan verschillen en ook van hun karakter afhangt. ■




Spel blijft belangrijk, óók voor volwassen katten.

CHECK OP AANDOENINGEN!
Was uw kat altijd heel speels en nu plotseling niet meer? Dan zou het zomaar eens kunnen zijn dat er hier een lichamelijke oorzaak voor is. Katten kunnen al vanaf zeven jaar artrose ontwikkelen, wat pijn bij het bewegen veroorzaakt. Maar ook andere aandoeningen kunnen ervoor zorgen dat uw kat zich niet fit en prettig voelt, waardoor hij niet meer graag speelt. Een bezoekje aan de dierenarts is daarom zeker aan te raden!







Deze zomer worden ze alweer vier: Mario en Lulu. Broer en zus, uit één nestje, opgegroeid in een huis met drie kinderen. En tóch vinden ze dat ze structureel knuffels tekortkomen. Ze trekken de hele wijk door, op jacht naar aandacht. Vooral na de zwemles – we wonen naast het zwembad – staan ze paraat. Het zijn twee luie goedzakken. Lulu begint altijd enthousiast aan haar eten, raakt halverwege afgeleid en komt dan verontwaardigd terug: huh, wie heeft mijn bakje leeggegeten?! Juist: Mario. Ze zijn een tikkie traag van begrip, maar iedereen houdt van ze.
Linda-Maria

Ook met uw huisdier in DenD? Mail naar post@dend.nl




HOU HET SPANNEND!
Elke dag hetzelfde doen? Dat zal veel mensen snel gaan vervelen en dat geldt ook voor onze viervoeters. Dat speelgoedmuisje dat daar al maanden in de woonkamer ligt? Niet meer interessant. Die speelhengel die al maanden uit de leuning van de bank steekt? Nog saaier. Zorg daarom voor afwisseling om uw kat geïnteresseerd te houden! Wissel speelgoed wat in de kamer ligt regelmatig af en ga actief samen spelen met de speelhengel. Maak hier een dagelijkse routine van en uw kat zal u vaak al zelf komen halen voor een speelkwartiertje! tinleygedragstherapie.nl


































































































KWAAROM KAN
EEN T-REX NIET IN ZIJN HANDEN KLAPPEN?

at heeft haar plekje gevonden. Meer nog: ze heeft vier kleintjes gekregen. Meestal gaat het goed. Miep, Mop, Bollie en Ferdinand spelen vrolijk met elkaar. Maar soms hebben ze het moeilijk. Dan is er te veel lawaai, kunnen ze niet goed tot rust komen of voelen ze zich onzeker en dom. Gelukkig zijn er Kat en haar dierenvrienden. Ze laten de kleintjes zien dat ze niet alleen zijn en leren hen eenvoudige trucjes om hun gevoelens een plekje te geven. De kleintjes van Kat is een warm en troostend prentenboek over lastige, maar heel normale gevoelens waar kinderen mee worstelen.







Nick Toet is geen man van ingewikkelde liflafjes. Niet in de keuken en al helemaal niet in het leven. Wie hem kent van zijn YouTube-kanaal EtenmetNick weet: hij gooit iets in de pan, kijkt hoe het uitpakt en gaat af op zijn gevoel. Dat doet hij ook als presentator van Taarten van Babel, het programma waarin kinderen niet alleen slagroom op taarten spuiten, maar ook hun hart uitstorten. Nick, hij groeide op in de Haagse volkswijk Laakkwartier) weet






precies hoe je een serieus gesprek voert zonder dat het zwaar wordt. „We gaan lekker praten en snoep in onze bekkies douwen”, zei hij enthousiast bij de aankondiging. Zijn gekste eetgewoonte?
„Hagelslag met pindakaas is te gek, of een broodje Snickers: dat is chocopasta met pindakaas.”
e een en ser e ie i us gesesprprek k r at het et zwawaar ar worordt d . kkeer pr p atten n en sn snoe o p iees s douwen e ”, ” , usisiasast t bi inng. g. g e? ? met et n ke k rss: ta a paast ”as. s







VAN TANJA





Uitgever: @999games
Leeftijd: vanaf 10 jaar
Spelers: 2
In dit tweepersoonsspel strijden de spelers om de heerschappij over de Great Plains. Door hun speelfiguren slim op het landschap te plaatsen, proberen ze terrein te veroveren. Daarbij krijgen ze soms hulp van geestendieren, die elk een unieke kracht hebben. Activeer je zo’n spirit animal, dan kun je met je pion grote sprongen maken. Ik ben altijd in voor een goed spel voor twee spelers, en dit is geen uitzondering. Het speelt snel en makkelijk, geluk speelt nauwelijks een rol, en er is volop interactie tussen de spelers. Het speelbord is elke keer anders omdat het uit losse tegels wordt opgebouwd. De spelkwaliteit is prima: dikke kartonnen borden en geestendieren, houten speelstukken. Voor mij is dit (bijna) het perfecte spel. Insta: boardgame_review_tanja

Vieze wc
Twee wc-potten staan naast elkaar. Zegt de ene pot tegen de ander: ‘Je hebt daar een vlekje’, Zegt de andere pot: ‘Hoe kun jij dat nou zien? Je hebt je bril niet eens op!’
De woorden hieronder zitten in alle richtingen verstopt. Sommige letters kunnen vaker gebruikt worden. Streep alle woorden af die je hebt gevonden. De letters die overblijven, zet je achter elkaar in de lege hokjes. Dat is de oplossing.
ARUBA BERMUDA
BIKINI
BONAIRE
BORNEO
CAPRI
CORSICA
CYPRUS
ELBA IBIZA
JAVA
KORFOE
KOS
KRETA
MALTA
NAXOS
SAMOS SEELAND SPITSBERGEN TENERIFE TIMOR TRINIDAD ZANZIBAR
In De jacht op de dierendief werkt Floris als vrijwilliger op de dierenambulance. Samen met zijn huisdier, Meneer Tortellini de slang, beleeft hij de spannendste avonturen. In dit grappige en mysterieuze verhaal ontdekt hij dat er een dierendief actief is in de stad waar hij werkt. Dit boek is geschreven door Floris Göbel. Floris deelt zijn liefde voor dieren en de natuur ook als presentator, influencer én als vrijwilliger op de dierenambulance.
WINNEN!

DenD geeft drie exemplaren van Dejachtopde dierendiefweg. Stuur je oplossing van de woordzoeker in op DenD.nl/puzzel om kans te maken.
voetbalterm deel v.h. been beeldraadsel loofboom Russisch heerser drietal grote bijl dierentuin in A'dam water in Utrecht invasie haast aanleg werkonwillige Europees gebergte met grote moeite geste geliefd
deel v.e. breuk handvat roem

Win een échte goudbaar van 1 gram!
Goud winnen klinkt als iets uit een film, maar deze maand is het écht mogelijk. Maxgoud Goudinkoop geeft een echte goudbaar van 1 gram weg. In februari 2025 dook Maxgoud op in de undercover goudtest van VARA/ Kassa. In dit consumentenprogramma gingen de makers op zoek naar de hoogste én eerlijkste goudprijs. Ze kwamen uit bij Maxgoud, waar Daphne de hoogste prijs bood – met transparante uitleg en vriendelijke service. maxgoud.com
WINNEN!DenD trakteert op een goudbaar van 1 gram van Maxgoud Goudinkoop! Stuur de oplossing van de puzzel in opDenD.nl/puzzel om kans te maken.


Zin om te schitteren? Dat kan met deze exclusieve Mr O by Otazu oorhangers van Maxgoud Goudinkoop. De elegante hangers zijn versierd met diepzwarte Swarovski-stenen en geven elke outfit een chique uitstraling. Perfect voor een avond uit, een feestje of gewoon om jezelf op een gewone dinsdag een beetje diva te voelen. maxgoud.com
Sommige mensen willen parfum. Anderen liever een dagje weg. En er zijn er ook die pas écht gelukkig worden van iets voor in huis of een nieuw paar sneakers. Wat geef je dan? Juist: een giftcard waarmee je alle kanten op kunt. Met de Good4fun cadeaubon kies je uit mode, sieraden, uitjes, boeken, gadgets en meer. Of je nu iets zoekt voor je schoonzus, je collega of jezelf (mag ook, vinden wij), het komt altijd goed. good4fun.nl
DenD verloot een Good4fun cadeaubon ter waarde van €50. Stuur de oplossing van de puzzel in opDenD.nl/puzzel om kans te maken. exc Go die een een dins max

WINNEN!






WINNEN!
DenD verloot deze zilveren Otazuoorhangers met zwarte Swarovski’s! Stuur de oplossing van de puzzel in op DenD.nl/puzzel om kans te maken.















Fietsen voor Sophia leverde dit jaar een ruim 7 ton op.


Dirk-collega’s in actie tijdens de nationale vrijwilligersdagen.








Dirk-medewerkers lopen mee voor het goede doel.
Bij Dirk staan we midden in de samenleving met aandacht voor onze klanten, collega’s en de buurt rondom onze winkels. Waar mogelijk, dragen we ons steentje bij. Niet alleen met geld, maar ook met producten of een helpende hand.
Het is inmiddels een Dirk-traditie: in maart krijgt elke Dirk-winkel de mogelijkheid om mee te doen aan NLdoet. Niet voor niets, want bij Dirk zijn we betrokken bij de buurt en helpen we graag een handje mee. Tijdens nationale vrijwilligersdagen steken Dirk-collega’s daarom de handen uit de mouwen. Ze knappen tuinen op, schilderen op de kinderboerderij of luisteren naar de verhalen van anderen.
Ook voor het Erasmus MC Sophia Kinderziekenhuis komt Dirk elk jaar in actie. Afgelopen maart deden honderd Dirk-collega’s mee aan het grootste spinningevenement van Nederland: Fietsen voor Sophia. Twee uur lang werkten zij zich in het zweet voor het Kinderhart van het kinderziekenhuis. Hun inzet werd beloond: samen trapten zij een recordbedrag
van €26.500 bij elkaar. In totaal werd er die dag maar liefst €802.125 opgehaald. Ieder kind verdient een goede start in het leven. Daarom steunt Dirk ook dit jaar weer de 538 Ochtendrun en het Prinses Máxima Centrum. Vijftien collega’s liepen mee namens Dirk, die niet alleen hun deelname mogelijk maakte, maar ook zorgde voor flesjes drinken, vers fruit en tussendoortjes voor alle lopers en vrijwilligers in het Olympisch Stadion. ■
Sponsorloop ‘538 Ochtendrun’ is voor Jade en haar lotgenootjes. Jade heeft te horen gekregen dat ze niet meer beter wordt. Haar missie is om lotgenoten te helpen met meer geld voor onderzoek, zodat er meer kinderen kunnen genezen. De opbrengst wordt gebruikt om een celsorteerapparaat aan het Prinses Máxima Centrum te schenken. Dit apparaat draagt bij aan de ontwikkeling van betere immunotherapie voor kinderen met kanker. Dit jaar werd er een indrukwekkend bedrag opgehaald: maar liefst €790. 542.














Met een tafel vol Santa Maria producten kan iedereen zijn eigen favoriete Taco samenstellen. Organiseer in een handomdraai een smakelijke Taco avond! Vul bakjes met groenten, vlees en vis gekruid met Taco Seasoning Mix, en laat iedereen een taco naar smaak vullen. Probeer ook eens met de soft tortilla’s original mini’s!































DenD en Oranje Boven zijn de grootste gratis redactioneel onafhankelijke familiebladen van Nederland met een oplage van 650.000 exemplaren. Gratis meenemen bij de meer dan 130 supermarkten van Dirk van den Broek en 44 Dirck3-slijterijen.
Ga naar www.dend.nl voor het actuele entertainment- en royaltynieuws.
Uitgever
Brookland Productions, Sassenheim
Concept, realisatie en redactie
Trusted Media Publishers
Fotografie
Johannes Dalhuijsen, ANP/ Hollandse Hoogte o.a.: Edwin Jansen, Anneke Jansen, Patrick Harderwijk en Robin Utrecht, Flickr, Unsplash, Instagram, Facebook, Netflix, Jurjen Donkers
Adres redactie DenD

Trusted Media Publishers
Donauweg 10 1043 AJ Amsterdam
DenD wordt verspreid via: alle Dirk van den Broek-supermarkten en Dirck3-slijterijen
Niets in deze uitgave mag, in welke vorm en op welke wijze dan ook, worden overgenomen zonder voorafgaande schriftelijke toestemming van de uitgever. Hoewel DenD met de grootst mogelijke zorgvuldigheid wordt samengesteld, staan uitgever en redactie niet in voor eventuele onvolkomenheden in de inhoud en kunnen hiervoor niet aansprakelijk worden gesteld. Niet alle in de advertenties genoemde producten zijn verkrijgbaar in de winkels die hieronder worden genoemd.


H&M: hm.com
Loberon: loberon.nl
Maison Berger: maison-berger.nl



Pandora: nl.pandora.net/nl
Pink Gellac: pinkgellac.com/nl
Swatch: swatch.com/nl














probeer nu













































































Op zoek naar een lekker en verantwoord tussendoortje? Probeer eens de Goed Bezig! repen van Bolletje. Lekker knapperig gebakken en vol granen, vezels én smaak. Of onze Zaden & Pitten repen Zonnebloempit met maar liefst 60% zaden en pitten. Voor elk moment van de dag een